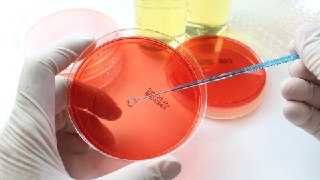
photo_2025-10-22_16-00-53.jpg

Оперативний ЗСУ
[TRANSLATED MESSAGE]
❗️Внаслідок the shelling of the railway in Sumy region damaged rolling stock and railway infrastructure, the movement of a number of trains is hampered - Ukrzaliznytsia
In some areas, there is no voltage in the contact network.
Two employees of the locomotive crew were hospitalized for examination.
Trains No. 144 Rakhiv - Sumy and No. 787 Tereshchenska - Kyiv have been suspended until the security situation improves. The delay time will be announced later.
Suburban train #6888 Sumy - Lebedynska is delayed for departure for an indefinite period of time. Traffic will be resumed as soon as the situation allows.
Changes have been made to suburban routes: train #6012 will run on the route Sumy - Trostyanets-Smorodyne (instead of Vorozhba - Trostyanets-Smorodyne).
The region uses a combined bus + train service. Due to the lack of power, a number of suburban trains will run with delays.
In Dnipropetrovska and Kharkivska regions, due to the increased danger and lack of power in certain areas, suburban routes may be changed and delays of up to 1.5 hours are possible.
https://t.me/operativnoZSU/
t.me/operativnoZSU/194979 ↩
- 23 October 2025 (582 messages)

 Obozrevatel.ua
Obozrevatel.ua
[TRANSLATED MESSAGE]
92 enemy UAVs shot down/suppressed - Air Force
On the night of October 23, the enemy attacked with 130 Shahed, Gerbera and other types of attack UAVs from the following directions: Kursk, Millerovo, Shatalovo, Orel, Primorsko-Akhtarsk - Russian Federation, Chauda - TOT of Crimea, about 80 of them were Shahed.
According to preliminary data, as of 08:30, air defense shot down/down 92 enemy Shahed, Gerbera and other types of UAVs in the north and east of the country.
The Ukrainian air defense recorded 25 strike UAVs at 11 locations, as well as the fall of downed UAVs (wreckage) at 11 locations.
Details
t.me/uaobozrevatel/193329 ↩ Оперативний ЗСУ
Оперативний ЗСУ
[TRANSLATED MESSAGE]
92/130 ENEMY AIRBORNE VEHICLES WERE SHOT DOWN/INJURED
25 attack UAVs were spotted in 11 locations, and the downed ones fell (wreckage) in 11 locations.
The attack continues, with several enemy UAVs in the airspace. Please follow the safety rules!
https://t.me/operativnoZSU/
t.me/operativnoZSU/194978 ↩ ЛС: новини Львів
ЛС: новини Львів
[TRANSLATED MESSAGE]
We have prepared contingency plans in case of new attacks in Lviv region - OVA.
The region and each community already know what to do if the gas or power grids are damaged, so as not to leave hospitals, schools and other important facilities without heat, water and electricity.
Send us photos/videos/information ➡️ @lviv24x7_bot
🇺🇦 LS: Lviv news
t.me/c/1687769706/45032 ↩ Реальна Війна | Україна | Новини
Реальна Війна | Україна | Новини
[TRANSLATED MESSAGE]
❗️Загроза ballistics! There was a target on Kyiv, now there is no target. Be attentive to the sound of the gunfire!
🇺🇦Реальна War | Subscribe
t.me/voynareal/124508 ↩ STERNENKO
STERNENKO
[TRANSLATED MESSAGE]
The threat of ballistics.
Chernihiv region was under attack.
Death to the Russians!
t.me/ssternenko/51001 ↩ Obozrevatel.ua
Obozrevatel.ua
[TRANSLATED MESSAGE]
‼ WARNING
WARNING: Threat of ballistic missile attack from Bryansk!
t.me/uaobozrevatel/193328 ↩ Инсайдер Киев
Инсайдер Киев
[TRANSLATED MESSAGE]
Target for Kiev/region
Insider Kiev
t.me/KyivPolitic/56154 ↩ Труха⚡️Україна
Труха⚡️Україна
[TRANSLATED MESSAGE]
Aim for Kyiv!
t.me/c/1199360700/124234 ↩ Оперативний ЗСУ
Оперативний ЗСУ
[TRANSLATED MESSAGE]
❗️Київ and a number of regions - ballistic threat from Bryansk region
A high-speed target for Kyiv!
https://t.me/operativnoZSU/
t.me/operativnoZSU/194977 ↩ Obozrevatel.ua
Obozrevatel.ua
[TRANSLATED MESSAGE]
‼️УВАГА! An air raid alert has been declared in Kyiv!
We ask everyone to immediately go to civil defense shelters!
t.me/uaobozrevatel/193327 ↩ INSIDER UA
INSIDER UA
[TRANSLATED MESSAGE]
❗️Угроза ballistics in Kyiv and in regions where an air alert has been declared
Subscribe to INSIDER UA | Submit content
t.me/insiderUKR/109555 ↩ Труха⚡️Україна
Труха⚡️Україна
[TRANSLATED MESSAGE]
Kyiv, alert!
t.me/c/1199360700/124233 ↩ Инсайдер Киев
Инсайдер Киев
[TRANSLATED MESSAGE]
❗️Угроза ballistics in Kyiv and in regions where an air alert has been declared
Insider Kiev
t.me/KyivPolitic/56153 ↩ STERNENKO
STERNENKO
[TRANSLATED MESSAGE]
At night, drones attacked the Ryazan refinery, which had been on Trump's sanctions list the day before.
The governor said the fire was caused by falling "debris."
t.me/ssternenko/50997 ↩ STERNENKO
STERNENKO
t.me/ssternenko/51000 ↩ STERNENKO
STERNENKO
t.me/ssternenko/50998 ↩ Obozrevatel.ua
Obozrevatel.ua
[TRANSLATED MESSAGE]
Russians attack Kyiv's residential infrastructure for second day in a row, - KIEV
"Last night, enemy drones attacked the city again. It was a fundamentally civilian, residential infrastructure. There are damages at 10 locations in Podil, Obolon and Desnianskyi districts. We have recorded direct hits by drones on residential buildings. These are all signs of targeted terror," said Timur Tkachenko, head of the KMIA.
▪️Сильно Podilskyi district was hit: educational institutions, religious buildings, a museum, and business districts were damaged.
▪️В In Obolon district, a drone flew into the 15th floor of a residential building.
▪️ In Desnianskyi district, the same direct hit to the 21st floor.
So far, seven people have been reported injured.
Details
t.me/uaobozrevatel/193323 ↩ Obozrevatel.ua
Obozrevatel.ua
t.me/uaobozrevatel/193325 ↩ Obozrevatel.ua
Obozrevatel.ua
t.me/uaobozrevatel/193326 ↩ Obozrevatel.ua
Obozrevatel.ua
t.me/uaobozrevatel/193324 ↩ Ukraine NOW
Ukraine NOW
[TRANSLATED MESSAGE]
The United States imposed sanctions against Russian oil companies Rosneft and Lukoil
The U.S. Treasury Department explained that the decision was made due to Russia's lack of readiness for a peace process to end the war against Ukraine.
Treasury Secretary Bessent called on Moscow to "immediately cease fire" and on US allies to join the restrictions.
t.me/UkraineNow/76027 ↩ МВС України
МВС України
[TRANSLATED MESSAGE]
🔴Russian troops attacked a railway station in Sumy region with a drone strike
Preliminary, two railway workers were injured.
Rescuers at the scene examined the area of the hit and provided the necessary assistance.
🇺🇦Підписатися | Minister | Ministry of Internal Affairs | Offensive Guard
t.me/mvs_ukraine/55317 ↩ МВС України
МВС України
t.me/mvs_ukraine/55319 ↩ МВС України
МВС України
t.me/mvs_ukraine/55318 ↩ INSIDER UA
INSIDER UA
t.me/insiderUKR/109554 ↩ Obozrevatel.ua
Obozrevatel.ua
[TRANSLATED MESSAGE]
Last night, occupants attacked a railway station in Sumy region with a drone strike - SES
Preliminary, two railway workers were injured.
t.me/uaobozrevatel/193320 ↩ Obozrevatel.ua
Obozrevatel.ua
t.me/uaobozrevatel/193322 ↩ Obozrevatel.ua
Obozrevatel.ua
t.me/uaobozrevatel/193321 ↩ Ukraine NOW
Ukraine NOW
[TRANSLATED MESSAGE]
Russian troops attack rescuers in Kharkiv region
While extinguishing a fire caused by an enemy drone strike in the village of Zelenyi Hai, Velykoburlutska community, Kupiansk district, Russian terrorists fired again at the place where rescuers were working. One rescuer was killed and five of his colleagues were wounded.
t.me/UkraineNow/76026 ↩ Оперативний ЗСУ
Оперативний ЗСУ
[TRANSLATED MESSAGE]
General Staff report as of 08:00, main:
▪️Протягом 126 combat engagements took place over the last day, 50 of them in the Pokrovsk sector.
▪️Противник used 29 missiles and dropped 176 guided bombs to strike Ukraine. In addition, it carried out 4,847 attacks, including 106 from multiple launch rocket systems, and used 6,530 kamikaze drones.
▪️За Over the past day, the aviation, missile troops and artillery of the Defense Forces hit four areas of concentration of personnel, weapons and military equipment, an ammunition depot, an artillery vehicle and two control points of the Russian invaders' UAVs.
https://t.me/operativnoZSU/
t.me/operativnoZSU/194976 ↩ Obozrevatel.ua
Obozrevatel.ua
[TRANSLATED MESSAGE]
Ukrainian troops advance in Dobropillia area and near Pokrovsk: ISW analysis
Ukrainian troops are holding back the enemy and conducting counteroffensive operations in the Pokrovsk sector. As a result of active actions, the defenders managed to advance in the area of Dobropillia and near Pokrovsk.
Ukrainian troops also captured dozens of Russian prisoners in this area of the front. This is stated in the analysis of the Institute for War Studies.
Read more
t.me/uaobozrevatel/193319 ↩ Ukraine NOW
Ukraine NOW
[TRANSLATED MESSAGE]
Enemy attacked a railway station in Sumy community with a UAV: railway workers were injured
"A 35-year-old man was hospitalized with a wound, doctors are providing the necessary assistance - there is no threat to his life. The second victim was treated on the spot," said Oleh Hryhorov, head of the Sumy Regional Military Administration.
✅ We are on WhatsApp | Viber | Telegram
t.me/UkraineNow/76025 ↩ МВС України
МВС України
[TRANSLATED MESSAGE]
❕7 people injured in night attack on Kyiv
🔹In Podilskyi district, rescuers extinguished a fire in a five-story apartment and cars in the yard. The residents were evacuated.
The facade and windows of a kindergarten, as well as one of the district's business centers, were damaged. Warehouses at several addresses were on fire.
In Desnianskyi district, a Russian UAV hit the 21st floor of a residential high-rise without detonation. Another hit was recorded in an unfinished building.
All fires have been extinguished. More than 100 rescuers and 28 pieces of equipment of the State Emergency Service were involved in eliminating the consequences of the enemy attack.
🇺🇦Підписатися | Minister | Interior Ministry | Offensive Guard
t.me/mvs_ukraine/55312 ↩ МВС України
МВС України
t.me/mvs_ukraine/55315 ↩ МВС України
МВС України
t.me/mvs_ukraine/55316 ↩ МВС України
МВС України
t.me/mvs_ukraine/55314 ↩ МВС України
МВС України
t.me/mvs_ukraine/55313 ↩ INSIDER UA
INSIDER UA
t.me/insiderUKR/109548 ↩ INSIDER UA
INSIDER UA
t.me/insiderUKR/109550 ↩ INSIDER UA
INSIDER UA
t.me/insiderUKR/109549 ↩ INSIDER UA
INSIDER UA
t.me/insiderUKR/109547 ↩ INSIDER UA
INSIDER UA
t.me/insiderUKR/109546 ↩ Україна 24/7 - новини
Україна 24/7 - новини
[TRANSLATED MESSAGE]
🔥 At night the good drones attacked Ryazan and Skopin.
The target of the attack was the Dyagilevo airfield and the refinery.
Ukraine 24/7
t.me/ukraina_novosti/101688 ↩ STERNENKO
STERNENKO
[TRANSLATED MESSAGE]
If you think that Trump will change his shoes tomorrow and lift the sanctions, throw your morning 5 hryvnias at the Russian cutter!
If you believe that Trampenko is our Cossack, throw 6 hryvnias to the chess cutter!
Let's see who wins!!!!
t.me/ssternenko/50996 ↩ Ukraine NOW
Ukraine NOW
[TRANSLATED MESSAGE]
7 people injured in night attack on Kyiv
Three residential buildings caught fire. The blast wave damaged windows in several buildings at different addresses. More than 40 windows were destroyed in one of the schools. In a kindergarten, some of the windows were smashed. Debris fell near the synagogue, - Mayor Klitschko.
t.me/UkraineNow/76024 ↩ Obozrevatel.ua
Obozrevatel.ua
[TRANSLATED MESSAGE]
State Emergency Service of Ukraine reports on the response to the Russian attack on Kyiv
▪️У In Podil district, firefighters extinguished a fire in an apartment on the first floor of a five-story residential building and cars in the yard. Emergency workers evacuated the residents.
In addition, the roof and two apartments on the 8th floor of one of the high-rise buildings partially collapsed. The facade and window glazing of one of the kindergartens were damaged.
A fire was also extinguished in warehouse buildings at several addresses and two cars caught fire in the yard of a five-story building. One of the business centers in Podilskyi district was damaged as a result of falling debris.
▪️У In the Desnianskyi district of the city, a Russian UAV hit the 21st floor of a residential twenty-four-story building without detonating. At another address, it hit an unfinished building. More than 100 rescuers and 28 units of SES equipment were involved in eliminating the consequences of the enemy attack.
t.me/uaobozrevatel/193312 ↩ Obozrevatel.ua
Obozrevatel.ua
t.me/uaobozrevatel/193317 ↩ Obozrevatel.ua
Obozrevatel.ua
t.me/uaobozrevatel/193315 ↩ Obozrevatel.ua
Obozrevatel.ua
t.me/uaobozrevatel/193318 ↩ Obozrevatel.ua
Obozrevatel.ua
t.me/uaobozrevatel/193316 ↩ Obozrevatel.ua
Obozrevatel.ua
t.me/uaobozrevatel/193314 ↩ Obozrevatel.ua
Obozrevatel.ua
t.me/uaobozrevatel/193313 ↩ Obozrevatel.ua
Obozrevatel.ua
[TRANSLATED MESSAGE]
Consequences of Russia's attack on Kyiv
In the Podil district of the capital:
- fires broke out in three residential buildings;
- the blast wave damaged windows in several buildings at different addresses;
- more than 40 windows were smashed in a school in the district;
- some of the windows in a kindergarten were damaged;
- cars were burning in the yards of several residential buildings, debris fell near the synagogue.
In Obolonsky district, a blast wave caused by a UAV downing damaged windows in a residential building.
t.me/uaobozrevatel/193311 ↩ Инсайдер Киев
Инсайдер Киев
[TRANSLATED MESSAGE]
As a result of the enemy attack on the capital and the fall of UAV wreckage this night in the Podolsk district:
▪️произошли fires in three residential houses;
▪️взрывной wave damaged windows in several houses at different addresses;
▪️в one of the district's schools had more than 40 windows blown out, and part of the windows in a kindergarten were damaged;
▪️горели cars in the yards of several residential buildings;
▪️обломки fell near a synagogue.
In Obolonskiy district the windows in one of the residential houses were damaged by a blast wave as a result of a UAV shooting down.
Insider Kiev
t.me/KyivPolitic/56151 ↩ Obozrevatel.ua
Obozrevatel.ua
[TRANSLATED MESSAGE]
in the morning, occupants attacked a car with a drone in the central district of Kherson
A 49-year-old man who was in the car sustained explosive and closed head injuries, contusion and shrapnel wounds.
The victim was taken to hospital in moderate condition, the MVA said.
t.me/uaobozrevatel/193310 ↩ Оперативний ЗСУ
Оперативний ЗСУ
[TRANSLATED MESSAGE]
❗️На In Kupyansk region, enemy strikes again at rescuers extinguishing fire - one killed, five wounded - SES
A fire raged in the village of Zelenyi Hai in the Velykoburlutska community of Kupiansk district after a drone strike. The SES team arrived to extinguish the fire, during which the enemy killed one of the specialists, Yuriy Chistikov, with repeated shelling. Five more of his colleagues were injured.
https://t.me/operativnoZSU/
t.me/operativnoZSU/194971 ↩ Оперативний ЗСУ
Оперативний ЗСУ
t.me/operativnoZSU/194973 ↩ Оперативний ЗСУ
Оперативний ЗСУ
t.me/operativnoZSU/194974 ↩ Оперативний ЗСУ
Оперативний ЗСУ
t.me/operativnoZSU/194972 ↩ Труха⚡️Україна
Труха⚡️Україна
t.me/c/1199360700/124229 ↩ STERNENKO
STERNENKO
[TRANSLATED MESSAGE]
🇺🇸Трамп: "The WSJ story that the US has authorized Ukraine to use long-range missiles deep inside Russia is FAKE NEWS! The US has nothing to do with these missiles."
😏Okay
t.me/ssternenko/50995 ↩ ЛС: новини Львів
ЛС: новини Львів
[TRANSLATED MESSAGE]
Today in Lviv region it will be warm and without significant precipitation
Light fog at night and in the morning. Southeast wind, 9 - 14 m/s. Temperature at night will be 3 - 8° Celsius, during the day 14 - 19° Celsius.
Send us photos/videos/information ➡️ @lviv24x7_bot
🇺🇦 LS: Lviv news
t.me/c/1687769706/45030 ↩ Инсайдер Киев
Инсайдер Киев
[TRANSLATED MESSAGE]
7 injured in overnight attack - Klitschko
Insider Kiev
t.me/KyivPolitic/56149 ↩ Obozrevatel.ua
Obozrevatel.ua
[TRANSLATED MESSAGE]
Kyiv: 7 injured in the capital after enemy attack last night. 5 of them were hospitalized. Two are on outpatient treatment.
t.me/uaobozrevatel/193309 ↩ Obozrevatel.ua
Obozrevatel.ua
[TRANSLATED MESSAGE]
‼️ In Kharkiv region, a rescuer was killed and five of his colleagues were wounded in a repeated enemy strike
On the night of October 23, a true Hero, Chief Master Sergeant of the Civil Defense Service Yuriy Petrovych Chistikov, born in 1975, was killed while performing a combat mission in Kupiansk district. Yuriy is survived by his daughter.
While extinguishing a fire caused by an enemy drone strike in the village of Zelenyi Hai, Velykoburlutska community, Kupiansk district, Russian terrorists fired again at the place where the rescuers were working. The enemy attack claimed the life of a rescuer, and five of his colleagues were injured,
t.me/uaobozrevatel/193306 ↩ Obozrevatel.ua
Obozrevatel.ua
t.me/uaobozrevatel/193307 ↩ Obozrevatel.ua
Obozrevatel.ua
t.me/uaobozrevatel/193308 ↩ Оперативний ЗСУ
Оперативний ЗСУ
[TRANSLATED MESSAGE]
❗️Пізно in the evening, the enemy attacked Kyiv with UAVs - KMIA
Shrapnel damaged 5 locations in Podil district, one of which is a kindergarten. Five cars were also damaged.
An apartment building was damaged in Desnyanskiy district.
Four people were injured.
https://t.me/operativnoZSU/
t.me/operativnoZSU/194970 ↩ Оперативний ЗСУ
Оперативний ЗСУ
[TRANSLATED MESSAGE]
❗️Вночі enemy attacked the territory of the railway station in Sumy, two people were injured - MBA
https://t.me/operativnoZSU/
t.me/operativnoZSU/194969 ↩ Obozrevatel.ua
Obozrevatel.ua
[TRANSLATED MESSAGE]
"War takes the lives of the best": a combat medic from Ternopil region died at the front
A soldier from Ternopil region, Andriy Pastushenko, was killed in action against the Russian occupation army. The defender was only 31 years old.
The warrior's life ended on October 14, 2025.
t.me/uaobozrevatel/193305 ↩ Оперативний ЗСУ
Оперативний ЗСУ
[TRANSLATED MESSAGE]
+900☠️
Combat work of the Defense Forces over the past day in figures.
https://t.me/operativnoZSU/
t.me/operativnoZSU/194968 ↩ Obozrevatel.ua
Obozrevatel.ua
[TRANSLATED MESSAGE]
SAR: UAV in Dnipropetrovs'k region, heading for Lozova
t.me/uaobozrevatel/193304 ↩ Obozrevatel.ua
Obozrevatel.ua
[TRANSLATED MESSAGE]
🔥 The Armed Forces of Ukraine have displaced 920 occupants!
t.me/uaobozrevatel/193303 ↩ Obozrevatel.ua
Obozrevatel.ua
[TRANSLATED MESSAGE]
Three innovative drugs for cancer treatment will appear in Ukraine: who will be able to get them
The Government of Ukraine has expanded the list of medicines procured under managed access agreements. Three new cancer drugs have been added to the list.
These are Palbociclib, Inotuzumab ozogamicin and Gemtuzumab ozogamicin - the drugs will be free of charge for patients. This was reported by the Ministry of Health of Ukraine.
t.me/uaobozrevatel/193302 ↩ Obozrevatel.ua
Obozrevatel.ua
[TRANSLATED MESSAGE]
The Kremlin is creating conditions to justify the likely failure of peace talks: ISW reveals the aggressor's goals
The leadership of the aggressor country, Russia, continues to put forward maximalist demands for ending the war, tantamount to Ukraine's complete surrender. Nevertheless, the Kremlin is trying to shift the blame for the likely failure of peace talks to the West.
At the same time, the Russian authorities claim that they are ready for a constructive dialogue. This is stated in the analysis of the Institute for War Studies.
t.me/uaobozrevatel/193301 ↩ Obozrevatel.ua
Obozrevatel.ua
[TRANSLATED MESSAGE]
‼️Вночі enemy attacked a railway station in Sumy community with a UAV
Two railway workers were injured in the attack. A 35-year-old man was hospitalized with a wound, and doctors are providing the necessary assistance - there is no threat to his life.
The second victim was treated on the spot, the JMA said.
t.me/uaobozrevatel/193300 ↩ Obozrevatel.ua
Obozrevatel.ua
[TRANSLATED MESSAGE]
Snow, frosts, thunderstorms and sun: the Hydrometeorological Center reported on weather "swings" in Ukraine
In the coming days, the weather in Ukraine will change more than once due to the alternation of atmospheric fronts. Rainy days are expected, when the whole country will be covered with precipitation, as well as dry and sometimes sunny days. However, there will be almost no frosts and sleet - such "anomalies" will be local and short-term.
At the same time, we shouldn't expect a strong warming in the foreseeable future. This was stated by Natalia Ptukha, a forecaster at the Ukrainian Weather Center, in an exclusive interview with OBOZ.UA.
t.me/uaobozrevatel/193299 ↩ Obozrevatel.ua
Obozrevatel.ua
[TRANSLATED MESSAGE]
Unable to cope with Ukrainian attacks: Russia has begun to use reservists for additional protection of refineries
Russia has admitted that it is unable to cope with the attacks by the Ukrainian Defense Forces on refineries and other facilities in the aggressor country, which have become more frequent recently. In this regard, the Russian Ministry of Defense decided to engage reservists to protect them.
We are talking about Russians who have voluntarily signed a "contract to serve in the mobilization human reserve." First of all, they will "counteract drones," but first they will have to undergo special training.
Read more
t.me/uaobozrevatel/193298 ↩ Obozrevatel.ua
Obozrevatel.ua
[TRANSLATED MESSAGE]
"We have good conversations that lead to nothing." Trump says he doesn't want Putin to get all of Ukraine
United States President Donald Trump has explained why he canceled his previously planned meeting with Russian dictator Vladimir Putin. In particular, the American leader referred to his own feeling that such a meeting was futile.
In general, the US president's rhetoric towards Ukraine and Russia has changed again. For example, Trump admitted that his talks with the Kremlin leader "lead nowhere."
"All I can say is that we always have good conversations with Vladimir, but they don't lead to anything, they just don't lead to anything. So it's time to make a deal," he said.
Read more
t.me/uaobozrevatel/193297 ↩ Obozrevatel.ua
Obozrevatel.ua
[TRANSLATED MESSAGE]
"They are accomplices in Russia's crimes in Ukraine": European Parliament calls for tougher sanctions against Lukashenko's regime
The European Parliament has condemned the policies of the regime of self-proclaimed President Alexander Lukashenko and called for the immediate release of all political prisoners in Belarus. The adopted resolution also calls for tougher sanctions against the Belarusian authorities until they stop persecuting citizens and being complicit in the war against Ukraine.
The resolution, dedicated to the fifth anniversary of the falsified elections in Belarus, was supported by 458 MEPs, 18 voted against, and 84 abstained. The European Parliament refused to recognize the legitimacy of the 2020 and 2025 presidential elections, calling them a sham aimed at strengthening Lukashenka's dictatorship.
Read more
t.me/uaobozrevatel/193296 ↩ Obozrevatel.ua
Obozrevatel.ua
[TRANSLATED MESSAGE]
SAR: UAV flying in the direction of Pavlohrad
t.me/uaobozrevatel/193295 ↩- 22 October 2025 (1013 messages)
 Obozrevatel.ua
Obozrevatel.ua
[TRANSLATED MESSAGE]
EU agrees on 19th package of sanctions against Russia - Reuters
European Union countries have finally approved the 19th package of sanctions against the aggressor country Russia for its war against Ukraine. This package of restrictions includes the previously announced ban on imports of Russian natural gas, as well as new restrictions on travel of Russian "diplomats" to the EU and new sanctions on 117 vessels from Moscow's "shadow fleet."
This was officially announced by Denmark, which holds the EU presidency. The European Commission promises to make a corresponding announcement later. In turn, Reuters, citing diplomatic sources in the EU, adds four organizations associated with China's oil industry to the sanctions list.
Read more
t.me/uaobozrevatel/193294 ↩ Obozrevatel.ua
Obozrevatel.ua
[TRANSLATED MESSAGE]
"An airplane is just a platform": Ignat names hidden benefits that the transfer of Gripen fighters to Ukraine may contain
Any military aircraft is a platform for weapons. Therefore, the transfer of Swedish multi-role Gripen fighters to Ukraine will also include additional weapons from partners - missiles and bombs.
Yuriy Ihnat, head of the Communications Department of the Air Force of the Armed Forces of Ukraine, said this during a telethon. He noted that ammunition is currently in short supply on the battlefield.
According to Ihnat, Russia uses 6,000 KABs per month to strike at the territory of Ukraine. That is why the Ukrainian side needs additional aircraft platforms and munitions.
Read more
t.me/uaobozrevatel/193293 ↩ Obozrevatel.ua
Obozrevatel.ua
[TRANSLATED MESSAGE]
SAR: UAV in Zhytomyr region, heading southwest
t.me/uaobozrevatel/193292 ↩ Obozrevatel.ua
Obozrevatel.ua
[TRANSLATED MESSAGE]
French army must be ready for a shock clash with Russia: Chief of the General Staff announces deadline
The aggressor country of Russia "may be tempted to continue the war on the continent" and in three or four years, in one way or another, start hostilities against European countries. One way or another, the French army must be "ready for the shock" of such a clash, and France must continue to rearm.
This was stated at a hearing of the French Parliament's Defense Committee by Chief of the General Staff Fabienne Mandon. He noted that although Europe is generally stronger than Russia, the Kremlin believes otherwise, and this should be understood and remembered.
Read more
t.me/uaobozrevatel/193291 ↩ Україна 24/7 - новини
Україна 24/7 - новини
[TRANSLATED MESSAGE]
🇺🇸Я canceled meeting with Putin in Hungary. The impression is that we will not achieve the desired goal, but we will meet in the future - Trump.
Ukraine 24/7
t.me/ukraina_novosti/101687 ↩ INSIDER UA
INSIDER UA
[TRANSLATED MESSAGE]
❗️Рой drones on Kamenskoye, Dnipropetrovsk region. They are flying to attack Srednedneprovskaya HPP
Subscribe to INSIDER UA | Submit content
t.me/insiderUKR/109544 ↩ Важные истории
Важные истории
[TRANSLATED MESSAGE]
Blocking WhatsApp and Telegram. New US sanctions against the Russian Federation. Attack on Ukraine and strikes on Russian enterprises. Closure of "Violence.net". More about the main events of the day
🔵In Russia "partially restricted" the work of messengers WhatsApp and "Telegram". This was announced today by Roskomnadzor (RKN), noting that such a measure is necessary to "counteract criminals".
At least 34 regions of Russia have faced the blocking of messengers, notes "Na svyazi".
"[The RKN] will slowly clamp down on messengers. Including blocking not constantly, but randomly. First on fixed operators, then on mobile operators. More and more frequently, making it more and more difficult to use messengers. At some point they will block them altogether," Internet security expert Mikhail Klimarev comments on the blocking.
🔵The US Finance Ministry has announced the imposition of sanctions against two of Russia's largest oil companies - Rosneft and Lukoil. The restrictions also apply to 34 of their subsidiaries.
US President Donald Trump confirmed that his meeting with Vladimir Putin in Budapest will not take place. However, he plans to hold it "in the future".
The EU, meanwhile, approved the 19th package of sanctions against Russia, Reuters reports.
🔵The Russian army attacked Ukraine with drones and missiles on the night of October 22. Seven people were killed, including a 38-year-old woman with her six-month-old baby and 12-year-old daughter.
In Kharkiv, a drone hit a private kindergarten. A fire broke out there, teachers with children hid in the basement, later they were evacuated.
After the attack, the Ukrainian Energy Ministry reported the start of emergency power cuts in most regions of the country.
Ukrainian drones, in turn, attacked the Saransk Mechanical Plant, which is part of Rostec, and the Dagnotech oil refinery.
🔵The founder of "Violence.net" announced the closure of the center because of the law on "foreign agents".
"First we were banned from holding events. Then - to engage in educational activities. More and more people were afraid to approach us, more and more services refused to help, closing the victims' access to support. This circle around our future was narrowing, narrowing, narrowing - and now there was no space left for work," Rivina reported.
The "Violence.net" center appeared in 2015 as a non-profit organization to help victims of domestic violence.
👉 Read more on the Important Stories website
1337th day of full-scale war in Ukraine
YouTube | Telegram | X | Instagram
t.me/istories_media/10630 ↩ Реальна Війна | Україна | Новини
Реальна Війна | Україна | Новини
[TRANSLATED MESSAGE]
⚡️Я always felt that Putin wanted Ukraine in its entirety, not part of it - Trump
I think he's ready to negotiate now. We don't want him to get everything.
🇺🇦Реальна War | Subscribe
t.me/voynareal/124506 ↩ Труха⚡️Україна
Труха⚡️Україна
[TRANSLATED MESSAGE]
I've always felt that Putin wants to take everything, not part of it. I think he's ready to negotiate now, we don't want him to get everything." - Trump.
ТРУХА⚡️Україна | Send news
t.me/c/1199360700/124227 ↩ INSIDER UA
INSIDER UA
[TRANSLATED MESSAGE]
I always thought Putin wanted to get the whole thing, not pieces. I think he's ready to negotiate now. We don't want him to get the whole thing - Trump
Subscribe to INSIDER UA | Submit content
t.me/insiderUKR/109543 ↩ Obozrevatel.ua
Obozrevatel.ua
[TRANSLATED MESSAGE]
Slovakia may support the 19th package of EU sanctions against Russia: Fico names conditions
Robert Fico claims that Slovakia has managed to push through wording on energy and the automotive industry in the draft conclusions of the upcoming summit, which he had previously used to justify his support for sanctions against Russia.
According to the Slovakian prime minister, he will meet with German Chancellor Friedrich Merz before the summit to discuss energy and the automotive sector. Fico called the 19th package of sanctions "a good tool for negotiations".
Read more
t.me/uaobozrevatel/193288 ↩ INSIDER UA
INSIDER UA
[TRANSLATED MESSAGE]
We have the most nukes, Russia is second, China is third, but in 4-5 years they will equalize - Trump
Subscribe to INSIDER UA | Submit content
t.me/insiderUKR/109542 ↩ Obozrevatel.ua
Obozrevatel.ua
[TRANSLATED MESSAGE]
A Hungarian refinery processing Russian oil is on fire in Slovakia
On October 22, a fire broke out and is still raging at the MOL Magyarország refinery in Bratislava, Slovakia. MOL Magyarországú is owned by a Hungarian company and processes Russian oil supplied through the Druzhba pipeline.
There is no official information about the fire. However, there are several photos of the alleged fire online.
Details
t.me/uaobozrevatel/193286 ↩ Obozrevatel.ua
Obozrevatel.ua
t.me/uaobozrevatel/193287 ↩ INSIDER UA
INSIDER UA
[TRANSLATED MESSAGE]
❗️Несколько hoards of UAVs to Dnipropetrovsk region from different directions
Subscribe to INSIDER UA | Submit content
t.me/insiderUKR/109541 ↩ Obozrevatel.ua
Obozrevatel.ua
[TRANSLATED MESSAGE]
‼ WARNING
WARNING: ☄️ Threat of use of ballistic weapons!
t.me/uaobozrevatel/193285 ↩ Оперативний ЗСУ
Оперативний ЗСУ
[TRANSLATED MESSAGE]
❗️Київ and a number of areas are threatened by ballistics
https://t.me/operativnoZSU/
t.me/operativnoZSU/194967 ↩ Реальна Війна | Україна | Новини
Реальна Війна | Україна | Новини
[TRANSLATED MESSAGE]
❗️Київ - missile danger!
Ballistic missile threat from Voronezh.
🇺🇦Реальна War | Subscribe
t.me/voynareal/124505 ↩ Труха⚡️Україна
Труха⚡️Україна
[TRANSLATED MESSAGE]
The threat of ballistics! Alert in Kyiv and a number of regions!
t.me/c/1199360700/124226 ↩ Инсайдер Киев
Инсайдер Киев
[TRANSLATED MESSAGE]
❗️Угроза ballistics in Kyiv and in regions where an air alert has been declared
Insider Kiev
t.me/KyivPolitic/56146 ↩ Obozrevatel.ua
Obozrevatel.ua
[TRANSLATED MESSAGE]
‼️УВАГА! An air raid alert has been declared in Kyiv!
We ask everyone to immediately go to civil defense shelters!
t.me/uaobozrevatel/193284 ↩ INSIDER UA
INSIDER UA
[TRANSLATED MESSAGE]
❗️Угроза ballistics in Kyiv and in regions where an air alert has been declared
Subscribe to INSIDER UA | Submit content
t.me/insiderUKR/109540 ↩ Оперативний ЗСУ
Оперативний ЗСУ
[TRANSLATED MESSAGE]
Trump on Tomahawks:
'It takes at least 6 months to learn how to use Tomahawks' - Trump
"The only way is to test them in combat, but we're not going to do that."
https://t.me/operativnoZSU/
t.me/operativnoZSU/194966 ↩ Инсайдер Киев
Инсайдер Киев
[TRANSLATED MESSAGE]
Four injured in Kiev as a result of UAV attack
Insider Kiev
t.me/KyivPolitic/56145 ↩ INSIDER UA
INSIDER UA
[TRANSLATED MESSAGE]
⚡️Россия and Ukraine must fix current frontline positions and end hostilities - Trump
Subscribe to INSIDER UA | Submit content
t.me/insiderUKR/109538 ↩ STERNENKO
STERNENKO
t.me/ssternenko/50991 ↩ STERNENKO
STERNENKO
t.me/ssternenko/50992 ↩ STERNENKO
STERNENKO
t.me/ssternenko/50993 ↩ STERNENKO
STERNENKO
t.me/ssternenko/50994 ↩ Obozrevatel.ua
Obozrevatel.ua
[TRANSLATED MESSAGE]
UPD: Four victims of last night's hostile attack in Kyiv have been reported - KIEV
Details.
t.me/uaobozrevatel/193283 ↩ Оперативний ЗСУ
Оперативний ЗСУ
[TRANSLATED MESSAGE]
I felt it was time. We've been waiting a long time - trump on sanctions against russia
https://t.me/operativnoZSU/
t.me/operativnoZSU/194965 ↩ INSIDER UA
INSIDER UA
[TRANSLATED MESSAGE]
Every time I talk to Vladimir, I have good conversations, but then they go nowhere - Trump
Really?
Subscribe to INSIDER UA | Submit content
t.me/insiderUKR/109537 ↩ ЛС: новини Львів
ЛС: новини Львів
[TRANSLATED MESSAGE]
Good night. The main news of the past day:
➡️ Two people died as a result of carbon monoxide poisoning in Lviv region
❗️Опалювальний The season for the population in Lviv region is scheduled to start on November 1
⚖️ She was sentenced for aiding in the organization of a terrorist attack: a resident of Lviv region was tried in Dnipro
❗️Канабісу and psilocybin mushrooms worth more than UAH 3 million seized from a group of drug traffickers
👀 Ex-police officer suspected of heroin trafficking and bribery repairs kindergarten in Lviv
🚑 Regional hospital became part of University hospital
💸 The average pension in Lviv region is 5.9 thousand UAH
Send us photos/videos/information ➡️ @lviv24x7_bot
🇺🇦 LS: Lviv news
t.me/c/1687769706/45029 ↩ Важные истории
Важные истории
[TRANSLATED MESSAGE]
The U.S. has imposed sanctions on Rosneft and Lukoil. Trump confirmed the cancelation of the meeting with Putin in Budapest
🔵 The introduction of restrictions against the two largest oil companies of the Russian Federation was announced by the US Ministry of Finance.
The sanctions are introduced "due to Russia's lack of serious commitment to the peace process aimed at ending the war in Ukraine," the agency emphasized.
The Finance Ministry added that the sanctions would also affect 34 subsidiaries of Rosneft and Lukoil.
🔵Donald Trump said that the meeting with Vladimir Putin in Budapest has been canceled. According to him, it may take place "in the future". On the eve of the cancellation of the meeting was reported by the media, citing sources.
YouTube | Telegram | X | Instagram
t.me/istories_media/10629 ↩ Труха⚡️Україна
Труха⚡️Україна
[TRANSLATED MESSAGE]
🤷♂️Потрібно at least 6 months to learn how to use Tomahawks. The only way is if we launch them, but we're not going to do that, Trump.
ТРУХА⚡️Україна | Send news
t.me/c/1199360700/124223 ↩ INSIDER UA
INSIDER UA
[TRANSLATED MESSAGE]
It takes at least 6 months to learn how to use Tomahawk missiles. The only way is to launch them, but we're not going to do that," is how Trump explains why he denied Ukraine missiles
Subscribe to INSIDER UA | Submit content
t.me/insiderUKR/109536 ↩ INSIDER UA
INSIDER UA
[TRANSLATED MESSAGE]
❗️Научиться to use Tomahawks in at least six months. The only way is if we launch them; we're not going to do that - Trump
Subscribe to INSIDER UA | Submit content
t.me/insiderUKR/109535 ↩ INSIDER UA
INSIDER UA
[TRANSLATED MESSAGE]
Trump on sanctions against Russian Federation: I felt it was time. We've been waiting a long time.
Subscribe to INSIDER UA | Submit content
t.me/insiderUKR/109534 ↩ Труха⚡️Україна
Труха⚡️Україна
[TRANSLATED MESSAGE]
❗️Я canceled his meeting with Putin, we will do it in the future - Trump.
ТРУХА⚡️Україна | Send news
t.me/c/1199360700/124221 ↩ INSIDER UA
INSIDER UA
[TRANSLATED MESSAGE]
❗️Я canceled the meeting with Putin. That was wrong. We will hold it in the future - Trump
Subscribe to INSIDER UA | Submit content
t.me/insiderUKR/109533 ↩ NEXTA Live
NEXTA Live
[TRANSLATED MESSAGE]
British Navy intercepts Russian warship off its coast on NATO orders
In the North Sea, the British destroyer HMS Duncan and a Wildcat helicopter intercepted the Russian anti-submarine ship Vice Admiral Kulakov, Sky News reported.
The operation was under direct orders from NATO and coordinated with the French Navy and the Dutch NH90 helicopter. The Russian ship entered the British surveillance zone and moved along the North Sea coast.
According to sources, this is the first time that British forces have acted on a direct order from the Alliance to intercept a Russian warship.
The Russian warship ...
@nexta_live
t.me/nexta_live/105207 ↩ INSIDER UA
INSIDER UA
[TRANSLATED MESSAGE]
The same UAV in Kiev that flew into a house and didn't explode. That was lucky.
Subscribe to INSIDER UA | Submit content
t.me/insiderUKR/109532 ↩ Инсайдер Киев
Инсайдер Киев
[TRANSLATED MESSAGE]
The same UAV in Kiev that flew into a house and didn't explode. That was lucky.
Insider Kiev
t.me/KyivPolitic/56140 ↩ INSIDER UA
INSIDER UA
[TRANSLATED MESSAGE]
Lukoil and Rosneft shares hit bottom after US sanctions imposed
Subscribe to INSIDER UA | Submit content
t.me/insiderUKR/109530 ↩ INSIDER UA
INSIDER UA
t.me/insiderUKR/109531 ↩ Україна 24/7 - новини
Україна 24/7 - новини
[TRANSLATED MESSAGE]
❗️США impose sanctions against Lukoil and Rosneft.
Trump said russia should immediately agree to a ceasefire.
Ukraine 24/7
t.me/ukraina_novosti/101684 ↩ Україна 24/7 - новини
Україна 24/7 - новини
t.me/ukraina_novosti/101685 ↩ NEXTA Live
NEXTA Live
[TRANSLATED MESSAGE]
Czech Republic to donate radar surveillance satellite to Ukraine
The Czech Republic will build and hand over to Ukraine a satellite capable of taking images using radar scanning (SAR).
This is reported by Czech Radio. The technology makes it possible to obtain images of the Earth's surface in any weather and at any time of day.
The project was presented by Transport Minister Martin Kupka during the Czech Space Week.
Ukraine itself requested such assistance as it is now dependent on satellite data from foreign partners.
In the future, this satellite will become part of an orbital constellation that will provide Ukraine with navigation, communication and reconnaissance capabilities.
@nexta_live
t.me/nexta_live/105206 ↩ Obozrevatel.ua
Obozrevatel.ua
[TRANSLATED MESSAGE]
UPD: An apartment building was damaged in Desnianskyi district - KMVA
No fire and no casualties reported.
t.me/uaobozrevatel/193280 ↩ Инсайдер Киев
Инсайдер Киев
[TRANSLATED MESSAGE]
In Desnyanskyi district of the apartment building was damaged. Preliminarily without fire and casualties.
Insider Kiev
t.me/KyivPolitic/56138 ↩ Оперативний ЗСУ
Оперативний ЗСУ
[TRANSLATED MESSAGE]
Repeated explosions near Chelyabinsk 💥
https://t.me/operativnoZSU/
t.me/operativnoZSU/194964 ↩ Obozrevatel.ua
Obozrevatel.ua
[TRANSLATED MESSAGE]
US imposes sanctions on major Russian oil companies and calls on Russia to immediately agree to a ceasefire, Trump says
The US imposes sanctions against Lukoil and Rosneft
t.me/uaobozrevatel/193279 ↩ Инсайдер Киев
Инсайдер Киев
[TRANSLATED MESSAGE]
In the Podolsk district, damage was recorded in five places. Among them is a kindergarten. It is also known about 5 damaged cars.
Insider Kiev
t.me/KyivPolitic/56137 ↩ Оперативний ЗСУ
Оперативний ЗСУ
[TRANSLATED MESSAGE]
🇺🇸 Washington announces sanctions against Katsap's Rosneft and Lukoil.
https://t.me/operativnoZSU/
t.me/operativnoZSU/194963 ↩ Obozrevatel.ua
Obozrevatel.ua
[TRANSLATED MESSAGE]
UPD: Damage recorded at five locations in Podil district - KIEV
Among them is a kindergarten.
There are also 5 damaged cars.
Information on casualties or other damage to infrastructure is being clarified.
t.me/uaobozrevatel/193278 ↩ Реальна Війна | Україна | Новини
Реальна Війна | Україна | Новини
[TRANSLATED MESSAGE]
⚡️США impose mega-sanctions against Rosneft and Lukoil, - US Treasury
🇺🇦Реальна War | Subscribe
t.me/voynareal/124501 ↩ INSIDER UA
INSIDER UA
[TRANSLATED MESSAGE]
⚡️США urges Russia to immediately cease fire and begin real negotiations to end the war in Ukraine - U.S. Treasury Department
It has also become known that powerful new US sanctions against Russia target Rosneft and Lukoil.
Subscribe to INSIDER UA | Submit content
t.me/insiderUKR/109527 ↩ Труха⚡️Україна
Труха⚡️Україна
[TRANSLATED MESSAGE]
🔥The United States imposes sanctions against Lukoil and Rosneft, - the Ministry of Finance.
Against this backdrop, these companies' stocks went down.
ТРУХА⚡️Україна | Send news
t.me/c/1199360700/124217 ↩ Реальна Війна | Україна | Новини
Реальна Війна | Україна | Новини
[TRANSLATED MESSAGE]
😱 A Shahed flew into the apartment of a Kyivan and did not explode - local channels.
Now further exploration is underway in the capital and the region. There is destruction and damage to civilian infrastructure.
🇺🇦Реальна War | Subscribe
t.me/voynareal/124500 ↩ Труха⚡️Україна
Труха⚡️Україна
[TRANSLATED MESSAGE]
Local media reports that a UAV flew into a Kyiv apartment but did not detonate.
All the most important updates on the capital and the region are here: https://t.me/kyiv
t.me/c/1199360700/124216 ↩ INSIDER UA
INSIDER UA
[TRANSLATED MESSAGE]
❗️В Kiev UAV flew into the apartment of a high-rise building. Preliminarily, without detonation - local mass media
Subscribe to INSIDER UA | Send content
t.me/insiderUKR/109526 ↩ Важные истории
Важные истории
[TRANSLATED MESSAGE]
Trump said the US did not authorize Ukraine to use long-range missiles to strike Russia
US President Donald Trump called an article by The Wall Street Journal, which talked about lifting the restriction on the use of long-range missiles by Ukraine, a "fake". He wrote about this in his social network Truth Social.
"The US has nothing to do with these missiles, wherever they come from, and what Ukraine is doing with them!" - Trump asserted.
YouTube | Telegram | X | Instagram
t.me/istories_media/10628 ↩ Оперативний ЗСУ
Оперативний ЗСУ
[TRANSLATED MESSAGE]
In Podil district, according to preliminary information, the wreckage of a UAV fell on the roof of a residential building. At another address, debris fell near a residential building, - Klitschko
https://t.me/operativnoZSU/
t.me/operativnoZSU/194962 ↩ Obozrevatel.ua
Obozrevatel.ua
[TRANSLATED MESSAGE]
UPD: According to preliminary information, UAV wreckage fell on the roof of a residential building in Podil district - Klitschko
At another address, the wreckage fell near a residential building.
Emergency services are on their way.
t.me/uaobozrevatel/193276 ↩ Инсайдер Киев
Инсайдер Киев
[TRANSLATED MESSAGE]
⚡️В Podolsky district, according to preliminary information, UAV debris fell on the roof of a residential building. At another address, debris fell near a residential building.
Insider Kiev
t.me/KyivPolitic/56136 ↩ NEXTA Live
NEXTA Live
[TRANSLATED MESSAGE]
Australia is going to hold the Olympics in a river with crocodiles.
The organizing committee of the 2032 Olympics in Brisbane has approved the Fitzroy River in Queensland as the venue for the canoeing competition, despite the fact that it is inhabited by crocodiles.
The decision has already sparked protests from sports federations.
The Australian Rowing Association said the Fitzroy did not meet international standards because the river was full of creeks and dangerous predators.
"Crocodiles could deter foreign athletes," acknowledged the association's director Sarah Cook.
Australian athletes, then, are used to such an environment.
@nexta_live.
t.me/nexta_live/105204 ↩ Obozrevatel.ua
Obozrevatel.ua
[TRANSLATED MESSAGE]
UPD: A UAV fragment damaged a residential building in Obolon district, - KIAA
Preliminary, there were no casualties.
t.me/uaobozrevatel/193275 ↩ Инсайдер Киев
Инсайдер Киев
[TRANSLATED MESSAGE]
❗️Предварительно, the wreckage of a Shahed fell on a kindergarten.
Insider Kiev
t.me/KyivPolitic/56133 ↩ INSIDER UA
INSIDER UA
[TRANSLATED MESSAGE]
❗️В Kiev, preliminary, debris of "shahid" fell on a kindergarten - KSCA
Subscribe to INSIDER UA | Submit content
t.me/insiderUKR/109523 ↩ Труха⚡️Україна
Труха⚡️Україна
[TRANSLATED MESSAGE]
❗️Попередньо, a kindergarten in Kyiv was damaged, - KCIA chief Tkachenko.
Footage and details from Kyiv: https://t.me/kyiv
t.me/c/1199360700/124215 ↩ Реальна Війна | Україна | Новини
Реальна Війна | Україна | Новини
[TRANSLATED MESSAGE]
❗️В Kyiv racists attacked a kindergarten, - KMWA. The second terrorist attack on a kindergarten in a day. First Kharkiv, now the capital!
🇺🇦Реальна War | Subscribe
t.me/voynareal/124497 ↩ Obozrevatel.ua
Obozrevatel.ua
[TRANSLATED MESSAGE]
UPD: Preliminary, one of the locations is a kindergarten. We are clarifying, - Tkachenko
t.me/uaobozrevatel/193274 ↩ Obozrevatel.ua
Obozrevatel.ua
[TRANSLATED MESSAGE]
"Your brave compatriot": Sikorsky trolls Szijjártó with "Magyar" who helps Hungary get rid of oil dependence on Russia
Polish Foreign Minister Radoslaw Sikorski wished that the commander of the Armed Forces Unmanned Systems Force, Robert Brovdi ("Magyar"), would help Hungary get rid of Russian oil.
The Polish minister wrote about this on the social network X. He emphasized that Hungary could stop financing the Russian military machine and receive oil through Croatia.
Sikorski said he was proud of the Polish court, which ruled that sabotaging the invader was not a crime.
Read more
t.me/uaobozrevatel/193273 ↩ Реальна Війна | Україна | Новини
Реальна Війна | Україна | Новини
[TRANSLATED MESSAGE]
❗️Не the United States authorized Ukraine to use long-range missiles deep inside Russia - trump calls the WSJ article "fake news."
"The United States has nothing to do with these missiles, wherever they come from, and what Ukraine is doing with them."
🇺🇦Реальна War | Subscribe
t.me/voynareal/124496 ↩ Инсайдер Киев
Инсайдер Киев
[TRANSLATED MESSAGE]
In the Podolsk district, debris falling at three locations.
Insider Kiev
t.me/KyivPolitic/56132 ↩ Труха⚡️Україна
Труха⚡️Україна
[TRANSLATED MESSAGE]
❗️Стаття WSJ's report that the US allegedly allowed Ukraine to use long-range missiles in Russia is fake. The US has nothing to do with these missiles or how Ukraine uses them, Trump says.
ТРУХА⚡️Україна | Send news
t.me/c/1199360700/124214 ↩ Инсайдер Киев
Инсайдер Киев
[TRANSLATED MESSAGE]
We're running a follow-up on the Shaheds in Kiev. Preliminary clear.
Insider Kiev
t.me/KyivPolitic/56131 ↩ INSIDER UA
INSIDER UA
[TRANSLATED MESSAGE]
❗️Статья in WSJ that the U.S. has authorized Ukraine to use long-range missiles deep inside Russia is fake news - Trump
"The U.S. has nothing to do with these missiles, wherever they came from, and what Ukraine is doing with them."
Subscribe to INSIDER UA | Submit content
t.me/insiderUKR/109522 ↩ Obozrevatel.ua
Obozrevatel.ua
[TRANSLATED MESSAGE]
We are recording the fall of debris at three locations in Podil district of Kyiv, - Head of KCIA Timur Tkachenko
Information about the victims is being clarified.
t.me/uaobozrevatel/193272 ↩ Инсайдер Киев
Инсайдер Киев
[TRANSLATED MESSAGE]
❗️Повышенная ballistics threat for the coming night. The specific threat is energy.
Subscribe to INSIDER UA | Submit content
t.me/KyivPolitic/56129 ↩ INSIDER UA
INSIDER UA
[TRANSLATED MESSAGE]
❗️Повышенная ballistics threat for the coming night. The specific threat is energy.
Subscribe to INSIDER UA | Submit content
t.me/insiderUKR/109520 ↩ Obozrevatel.ua
Obozrevatel.ua
[TRANSLATED MESSAGE]
US lifts key restriction on Ukraine's use of long-range missiles - WSJ
The administration of U.S. President Donald Trump has lifted a "key restriction" on Ukraine's use of certain long-range missiles supplied by its Western partners. So far, it is only the Storm Shadow missiles provided to Ukrainian defenders by the United Kingdom.
This was reported by the Wall Street Journal, citing unnamed US officials. According to them, the decision was made by Trump to "force Moscow to start negotiations to end the war and at the same time not to provide Ukrainians with Tomahawk missiles."
Read more
t.me/uaobozrevatel/193271 ↩ Реальна Війна | Україна | Новини
Реальна Війна | Україна | Новини
[TRANSLATED MESSAGE]
❗️Загроза ballistics at a high level for Kyiv, as warned - strike UAVs over the capital with cameras.
Be attentive to the following messages, because there may be no end to the drones!
🇺🇦Реальна War | Subscribe
t.me/voynareal/124494 ↩ NEXTA Live
NEXTA Live
[TRANSLATED MESSAGE]
Z-warriors complain that the scumbags who killed American communist and "militia" member Russell Bentley will soon be released from prison and sent to the front.
In case you have forgotten, drunken "DNR" fighters mistook their American "camrade" for a spy and brutally tortured him in a basement.
Why were the heroes imprisoned in the first place? On the contrary, they should be rewarded for their diligent service. Spies will not get through!
If he doesn't speak Russian, shoot to kill, and then they'll sort it out.
Foreigners fighting on the side of the Russian Federation are fighting for such "Russian peace".
@nexta_live
t.me/nexta_live/105203 ↩ Инсайдер Киев
Инсайдер Киев
[TRANSLATED MESSAGE]
2 UAVs at CHPP-6
Insider Kiev
t.me/KyivPolitic/56128 ↩ Україна 24/7 - новини
Україна 24/7 - новини
[TRANSLATED MESSAGE]
Orban is going to visit Washington - Hungarian Foreign Minister Szijjártó.
He also said that the meeting between Putin and Trump would take place, the only question is its timing.
Ukraine 24/7
t.me/ukraina_novosti/101683 ↩ INSIDER UA
INSIDER UA
[TRANSLATED MESSAGE]
❗️РФ tries to leave Kyiv without light - right now "Shaheds" are attacking CHPP-6
Subscribe to INSIDER UA | Submit content
t.me/insiderUKR/109519 ↩ STERNENKO
STERNENKO
[TRANSLATED MESSAGE]
May the next day bring death and suffering to the Russians.
To do this, be sure to throw it on the Russian cutter for the night!
t.me/ssternenko/50989 ↩ Оперативний ЗСУ
Оперативний ЗСУ
[TRANSLATED MESSAGE]
Air defense forces are working on enemy UAVs in the capital, - Kyiv City State Administration
https://t.me/operativnoZSU/
t.me/operativnoZSU/194961 ↩ Obozrevatel.ua
Obozrevatel.ua
[TRANSLATED MESSAGE]
Air defense forces are working on enemy UAVs in the capital, - Klitschko
Stay in shelters!
t.me/uaobozrevatel/193270 ↩ Україна 24/7 - новини
Україна 24/7 - новини
[TRANSLATED MESSAGE]
❗️Сообщают about explosions in Kiev. Air defense is working.
Ukraine 24/7
t.me/ukraina_novosti/101682 ↩ Труха⚡️Україна
Труха⚡️Україна
[TRANSLATED MESSAGE]
❗️Дуже Drones are flying low over Kyiv, it's hard to fix them! Acoustically, there are about a dozen monitors.
All the most important updates on the capital and the region are here: https://t.me/kyiv
t.me/c/1199360700/124211 ↩ Реальна Війна | Україна | Новини
Реальна Війна | Україна | Новини
[TRANSLATED MESSAGE]
❗️В Kyiv is a danger to high-rise buildings - the height of the drones is about 100 meters. The drones have been circling over CHP-6 and are now headed for the hydroelectric power plant
🇺🇦Реальна War | Subscribe
t.me/voynareal/124493 ↩ NEXTA Live
NEXTA Live
[TRANSLATED MESSAGE]
What a night tonight! EU countries finally approve 19th package of sanctions against Russia
Apparently, the objections of Hungary and Slovakia have been overcome. We're waiting for more details!
So far we only know that the EU sanctions will affect Russian gas and shadow fleet. Russia will also face tougher U.S. sanctions.
@nexta_live
t.me/nexta_live/105202 ↩ Важные истории
Важные истории
[TRANSLATED MESSAGE]
⚡️ US announces new sanctions against Russia and lifts restriction on Ukraine's use of Western long-range missiles
The United States will announce a significant expansion of sanctions against Russia on Wednesday afternoon local time or Thursday morning, Treasury Department chief Scott Bessent said.
The Wall Street Journal reported on the lifting of the missile restriction, citing sources. According to the newspaper, it will allow Kiev to expand attacks on targets inside Russia and increase pressure on the Kremlin.
WSJ recalls that on October 21, the Ukrainian military struck a factory in Bryansk, which produces explosives and fuel. For the attack, the military used a British Storm Shadow cruise missile (an analog of Tomahawk with a shorter range).
At the same time, the EU member states approved the 19th package of sanctions against Russia, Reuters reports. It includes a ban on imports of Russian liquefied natural gas. If there are no objections, the package will be adopted by 8 a.m. tomorrow, the agency specifies.
YouTube | Telegram | X | Instagram
t.me/istories_media/10624 ↩ Obozrevatel.ua
Obozrevatel.ua
[TRANSLATED MESSAGE]
‼ WARNING
SAR: UAV flying towards Kyiv from the north.
t.me/uaobozrevatel/193269 ↩ Реальна Війна | Україна | Новини
Реальна Війна | Україна | Новини
[TRANSLATED MESSAGE]
❗️На At least 4 Shahids are flying to Kyiv! The alarm has been announced in the capital!
🇺🇦Реальна War | Subscribe
t.me/voynareal/124492 ↩ Инсайдер Киев
Инсайдер Киев
[TRANSLATED MESSAGE]
❗️Угроза UAVs in Kyiv and regions where an air alert has been declared
Insider Kiev
t.me/KyivPolitic/56127 ↩ Україна 24/7 - новини
Україна 24/7 - новини
[TRANSLATED MESSAGE]
❗️Угроза UAVs in Kyiv and areas where an air alert has been declared.
Ukraine 24/7
t.me/ukraina_novosti/101681 ↩ Труха⚡️Україна
Труха⚡️Україна
[TRANSLATED MESSAGE]
The threat of UAVs in Kyiv and regions where an alert has been issued.
t.me/c/1199360700/124210 ↩ INSIDER UA
INSIDER UA
[TRANSLATED MESSAGE]
❗️Угроза UAVs in Kyiv and regions where an air alert has been declared
Subscribe to INSIDER UA | Submit content
t.me/insiderUKR/109517 ↩ Obozrevatel.ua
Obozrevatel.ua
[TRANSLATED MESSAGE]
‼️УВАГА! An air raid alert has been declared in Kyiv!
We ask everyone to immediately go to civil defense shelters!
t.me/uaobozrevatel/193268 ↩ Оперативний ЗСУ
Оперативний ЗСУ
[TRANSLATED MESSAGE]
There is a "fart" for every Katsap!
https://t.me/operativnoZSU/
t.me/operativnoZSU/194960 ↩ Оперативний ЗСУ
Оперативний ЗСУ
[TRANSLATED MESSAGE]
Tonight or tomorrow morning, sanctions against Russia are expected to be significantly strengthened, - US Treasury Secretary Bessent
https://t.me/operativnoZSU/
t.me/operativnoZSU/194958 ↩ Україна 24/7 - новини
Україна 24/7 - новини
[TRANSLATED MESSAGE]
❗️Глава U.S. Treasury Department Bessant said they will announce a significant increase in sanctions against russia tonight or tomorrow morning.
Ukraine 24/7
t.me/ukraina_novosti/101680 ↩ NEXTA Live
NEXTA Live
[TRANSLATED MESSAGE]
❕ U.S. lifts key restriction on Ukraine's use of long-range missiles supplied by allies
This will allow Ukraine to step up attacks on targets inside Russia and put more pressure on the Kremlin.
The U.S. expects long-range missile strikes against Russian Federation to become more frequent.
In addition, the head of the US Treasury Department, Bessent, said they will announce a significant increase in sanctions against Russia tonight or tomorrow morning. Trump confirmed this.
@nexta_live.
t.me/nexta_live/105201 ↩ INSIDER UA
INSIDER UA
[TRANSLATED MESSAGE]
⚡️Москва, St. Petersburg, Yaroslavl and dozens of other major Russian cities are now within range of Ukraine's missiles
Subscribe to INSIDER UA | Submit content
t.me/insiderUKR/109516 ↩ Obozrevatel.ua
Obozrevatel.ua
t.me/uaobozrevatel/193265 ↩ Obozrevatel.ua
Obozrevatel.ua
t.me/uaobozrevatel/193264 ↩ Obozrevatel.ua
Obozrevatel.ua
t.me/uaobozrevatel/193266 ↩ STERNENKO
STERNENKO
[TRANSLATED MESSAGE]
U.S. Treasury Secretary Bessent announces tougher sanctions against Russia tomorrow.
t.me/ssternenko/50988 ↩ Труха⚡️Україна
Труха⚡️Україна
[TRANSLATED MESSAGE]
❗️Санкції against Russia will be significantly strengthened, we will announce today or tomorrow, - US Treasury Secretary Bessent.
Meanwhile, the EU has also approved the 19th package of sanctions against Russia.
ТРУХА⚡️Україна | Send news
t.me/c/1199360700/124209 ↩ Ukraine NOW
Ukraine NOW
[TRANSLATED MESSAGE]
⚡️Головні news for October 22:
▪️росія attacked the Ukrainian energy sector overnight
▪️ЗСУ occupants were driven out of Kucheriv Yar village in the Pokrovsk sector of Donetsk region
▪️росія is putting pressure on some European countries not to contribute to the PURL initiative, - Zelensky
▪️Україна will buy 120-150 newest Swedish Gripen fighters
t.me/UkraineNow/76023 ↩ Україна 24/7 - новини
Україна 24/7 - новини
[TRANSLATED MESSAGE]
❗️Послы eu approves 19th package of sanctions against rf - Reuters.
Ukraine 24/7
t.me/ukraina_novosti/101679 ↩ Реальна Війна | Україна | Новини
Реальна Війна | Україна | Новини
[TRANSLATED MESSAGE]
⚡️США expect Ukraine to launch new massive strikes on Russia with Storm Shadow missiles - they can be launched from Ukrainian aircraft and fly over 290 km - WSJ.
🇺🇦Реальна War | Subscribe
t.me/voynareal/124490 ↩ Оперативний ЗСУ
Оперативний ЗСУ
t.me/operativnoZSU/194956 ↩ Оперативний ЗСУ
Оперативний ЗСУ
t.me/operativnoZSU/194955 ↩ Реальна Війна | Україна | Новини
Реальна Війна | Україна | Новини
t.me/voynareal/124489 ↩ Obozrevatel.ua
Obozrevatel.ua
[TRANSLATED MESSAGE]
"Night attack shows that Putin does not want peace": Czech Republic calls for giving Ukraine ammunition and air defense before winter
"Russia's night attack on Ukraine is yet another proof that Putin wants war. He doesn't care about ceasefire proposals. That's why Putinism must be stopped," Czech Foreign Minister Jan Lipavsky wrote on social network X.
He added that it is necessary to strengthen the security of Ukraine and Europe. We need air defense systems, ammunition, and energy equipment to thwart Russian terror.
Read more
t.me/uaobozrevatel/193256 ↩ INSIDER UA
INSIDER UA
[TRANSLATED MESSAGE]
❗️США expect Ukraine to increase long-range attacks using Storm Shadow missiles, which are launched from Ukrainian aircraft and can travel more than 290 kilometers - WSJ
Subscribe to INSIDER UA | Submit content
t.me/insiderUKR/109514 ↩ Ukraine NOW
Ukraine NOW
[TRANSLATED MESSAGE]
First several billion US weapons have already been sent to Ukraine - Rutte
They were paid for by the allies. And, of course, the Europeans are stepping up when it comes to security guarantees for Ukraine after a long-term ceasefire or peace agreement. But of course, we all pray that this happens as soon as possible, the NATO Secretary General emphasized.
✅ We are on WhatsApp | Viber | Telegram
t.me/UkraineNow/76022 ↩ INSIDER UA
INSIDER UA
t.me/insiderUKR/109513 ↩ INSIDER UA
INSIDER UA
t.me/insiderUKR/109512 ↩ Оперативний ЗСУ
Оперативний ЗСУ
[TRANSLATED MESSAGE]
EU countries agree on 19th package of sanctions against Russia - Suspilne
https://t.me/operativnoZSU/
t.me/operativnoZSU/194951 ↩ Україна 24/7 - новини
Україна 24/7 - новини
[TRANSLATED MESSAGE]
❗️США has lifted a key restriction on Ukraine's use of allied-supplied long-range missiles, allowing the AFU to strike deep into rf - WSJ.
Ukraine 24/7
t.me/ukraina_novosti/101678 ↩ NEXTA Live
NEXTA Live
t.me/nexta_live/105198 ↩ INSIDER UA
INSIDER UA
[TRANSLATED MESSAGE]
❗️США has lifted a key restriction on Ukraine's use of allied-supplied long-range missiles, allowing the AFU to strike deep into Russia - WSJ
Subscribe to INSIDER UA | Submit content
t.me/insiderUKR/109508 ↩ Труха⚡️Україна
Труха⚡️Україна
[TRANSLATED MESSAGE]
❗️❗️США lifted a key restriction on Ukraine's use of long-range Western missiles.
ТРУХА⚡️Україна | Send news
t.me/c/1199360700/124208 ↩ Реальна Війна | Україна | Новини
Реальна Війна | Україна | Новини
[TRANSLATED MESSAGE]
❗️США lifted a key restriction on Ukraine's use of Western long-range missiles, U.S. officials say - WSJ
🇺🇦Реальна War | Subscribe
t.me/voynareal/124484 ↩ INSIDER UA
INSIDER UA
[TRANSLATED MESSAGE]
⚡️Графики blackouts for tomorrow in Kiev
Subscribe to INSIDER UA | Submit content
t.me/insiderUKR/109506 ↩ INSIDER UA
INSIDER UA
t.me/insiderUKR/109507 ↩ Инсайдер Киев
Инсайдер Киев
[TRANSLATED MESSAGE]
❗️Киев. Schedules for tomorrow
Insider Kiev
t.me/KyivPolitic/56125 ↩ Инсайдер Киев
Инсайдер Киев
t.me/KyivPolitic/56126 ↩ Труха⚡️Україна
Труха⚡️Україна
t.me/c/1199360700/124207 ↩ ЛС: новини Львів
ЛС: новини Львів
t.me/c/1687769706/45027 ↩ STERNENKO
STERNENKO
[TRANSLATED MESSAGE]
The Katsaps have set up a bot farm for a tweet about a Russian attack on a kindergarten in Kharkiv.
As usual, they deny reality, lie and invent.
All the more reason to share it!
t.me/ssternenko/50986 ↩ Obozrevatel.ua
Obozrevatel.ua
[TRANSLATED MESSAGE]
Russian drone kills a mother with a baby and a schoolgirl near Kyiv: only grandparents survive
On October 22, three members of the same family were killed during a Russian shelling in the village of Pohreby in the Kyiv region. The six-month-old girl Adelina Nehoda was her parents' only and long-awaited child. Her 38-year-old mother Antonina Zaichenko and her 12-year-old niece Anastasia Nehoda were killed along with her.
Read more about the tragedy in the OBOZ.UA article.
t.me/uaobozrevatel/193255 ↩ Инсайдер Киев
Инсайдер Киев
[TRANSLATED MESSAGE]
Dense fog will cover Kiev in the next hour. I level of danger, yellow.
Visibility will remain till the end of the day on October 22, at night and in the morning on October 23, visibility will be only 200-500 m.
Insider Kiev
t.me/KyivPolitic/56124 ↩ Реальна Війна | Україна | Новини
Реальна Війна | Україна | Новини
[TRANSLATED MESSAGE]
🇬🇧Вперше On direct order of NATO, British Navy intercepts Russian warship in its waters - Sky News
The operation to intercept the Russian destroyer "Vice Admiral Kulakov" in the North Sea involved the destroyer HMS Duncan and a Wildcat helicopter, as well as the French Navy and the Dutch NH90.
🇺🇦Реальна War | Subscribe
t.me/voynareal/124483 ↩ Труха⚡️Україна
Труха⚡️Україна
[TRANSLATED MESSAGE]
🥴EA has blocked all players from Zaporizhzhia, Kherson, Luhansk, and Donetsk regions, - the company's community manager.
Players from the non-occupied territories of Ukraine are also banned.
ТРУХА⚡️Україна | Send news
t.me/c/1199360700/124202 ↩ Труха⚡️Україна
Труха⚡️Україна
t.me/c/1199360700/124203 ↩ Труха⚡️Україна
Труха⚡️Україна
t.me/c/1199360700/124204 ↩ STERNENKO
STERNENKO
[TRANSLATED MESSAGE]
Explosions in Pavlohrad.
Ukraine is under attack by attack UAVs. There were launches from 4 directions.
Take care of yourself and be sure to subscribe to Shahedoriz!
t.me/ssternenko/50985 ↩ Україна 24/7 - новини
Україна 24/7 - новини
[TRANSLATED MESSAGE]
The British Navy has intercepted the Russian warship Vice Admiral Kulakov in its territorial waters - Sky News.
The destroyer HMS Duncan and a Wildcat helicopter were deployed in the North Sea to escort the Russian ship across the English Channel.
Ukraine 24/7
t.me/ukraina_novosti/101677 ↩ INSIDER UA
INSIDER UA
[TRANSLATED MESSAGE]
British navy intercepts Russian warship in its territorial waters: this is the first time a British ship has acted on direct orders from NATO rather than from London - Sky News
In the North Sea, the British destroyer HMS Duncan and a Wildcat helicopter intercepted the Russian ship Vice Admiral Kulakov. The French Navy and the Dutch NH90 helicopter also took part in the operation.
Subscribe to INSIDER UA | Submit content
t.me/insiderUKR/109505 ↩ Obozrevatel.ua
Obozrevatel.ua
[TRANSLATED MESSAGE]
Britain has lifted sanctions on two Rosneft subsidiaries, but there is a caveat
The UK government has eased sanctions against Russia and lifted restrictions on two subsidiaries of the Russian oil giant Rosneft that are controlled by the German government. This means that British companies will be able to freely enter into transactions with them without fear of being subject to secondary sanctions.
The easing of the sanctions regime was announced a week after the UK imposed new restrictions on Russia, which included Russian energy giants Rosneft and Lukoil. Read more.
t.me/uaobozrevatel/193254 ↩ Реальна Війна | Україна | Новини
Реальна Війна | Україна | Новини
[TRANSLATED MESSAGE]
⚠️Пуски from 6 (!) locations and all directions was launched by the Russian Federation at 6 p.m. - dozens of drones are already in the airspace, making their way to the targets.
Be careful during the night, as ballistics may be added to the drone threats, as it was today, in particular, in Kyiv.
🇺🇦Реальна War | Subscribe
t.me/voynareal/124482 ↩ NEXTA Live
NEXTA Live
[TRANSLATED MESSAGE]
"stores for the poor" are becoming popular in Russia
The exodus of shoppers from hypermarkets continues in Russia as more Russians opt for discounters and small outlets with a limited assortment.
According to Infoline, 67 large supermarkets and hypermarkets closed in the first nine months of 2025. This is a drop of 1.4% year-on-year.
Economists explain the trend by the fact that the purchasing power of Russians is declining and they are saving on literally everything.
@nexta_live
t.me/nexta_live/105196 ↩ 1-й корпус НГУ «Азов»
1-й корпус НГУ «Азов»
[TRANSLATED MESSAGE]
Azov soldiers together with fighters of the "Luty" brigade rescued a woman from the rubble in Kostyantynivka.
The local resident had to be rescued from the ruins of her own house after a Russian KAB hit.
Air defense shooters of the 12th Azov Brigade and fighters of the Joint Assault Brigade of the National Police "Luty" rescued the woman and her pet. The defenders also provided the victim with first aid.
Occupants are daily wiping out Kostyantynivka with all available munitions. Drones, air bombs, MLRS missiles and artillery shells are flying at the city and its residents. It is becoming more and more difficult to save the locals every day.
t.me/azov_media/7450 ↩ 1-й корпус НГУ «Азов»
1-й корпус НГУ «Азов»
t.me/azov_media/7453 ↩ 1-й корпус НГУ «Азов»
1-й корпус НГУ «Азов»
t.me/azov_media/7454 ↩ 1-й корпус НГУ «Азов»
1-й корпус НГУ «Азов»
t.me/azov_media/7451 ↩ 1-й корпус НГУ «Азов»
1-й корпус НГУ «Азов»
t.me/azov_media/7452 ↩ Obozrevatel.ua
Obozrevatel.ua
[TRANSLATED MESSAGE]
Russia restricts the work of foreign messengers: WhatsApp and Telegram are under the ban
In all regions of the aggressor country of Russia, such popular messengers as WhatsApp and Telegram have stopped working. Users of these applications have been massively reporting problems with the services since Tuesday, October 21. Today, such complaints have reached their peak.
Meanwhile, Roskomnadzor confirms "partial restriction of foreign messengers". Read more.
t.me/uaobozrevatel/193253 ↩ INSIDER UA
INSIDER UA
[TRANSLATED MESSAGE]
Lawyers targeted by NABU: Bureau bans them from communicating with media and continues political reprisals
The Bureau's investigation against the lawyers who were wiretapped by the NABU in 2023 is turning into a protracted saga - due to the violation of investigative jurisdiction and attempts to artificially leave the proceedings to the NABU, SAP and VAKS.
Suspicions are handed out chaotically. And the ban on commenting on cases in the media is a complete absurdity. As, in fact, everything that is happening in this case. NABU is trying to impose a political subtext on society, knowing in advance that it will lose in court.
Instead, detectives leak distorted information to friendly media, which "reflect" the versions of the investigation. Lawyers are preparing lawsuits against such media.
Interestingly, the versions of NABU detectives are based on audio recordings from the wiretapping, which was illegal. The equipment was discovered by the lawyers themselves - in their own office, in the meeting room where they were communicating with clients under investigation by the NABU.
Detectives seized part of the media without a court decision, and part - received "from unidentified persons" after a long time. That is, the recordings cannot be considered reliable evidence without expert examination.
"This case is proof that the leadership of the SAP and NABU forces subordinates to engage in political reprisals. We, lawyers, to whom NABU and SAP lost most of the cases, have now become their target. Instead of fighting corruption, they focused on political persecution and orders in a competitive environment," the lawyers' association said.
We will remind, in 2023 NABU installed wiretapping in the office of the capital lawyers. The equipment was mounted in the room for negotiations with clients who are investigated by the Bureau itself. The NABU called such actions a gross violation of attorney-client privilege. The ECHR has already accepted for consideration the applications of eight lawyers whose rights were violated by the NABU.
Subscribe to INSIDER UA | Send content
t.me/insiderUKR/109503 ↩ NEXTA Live
NEXTA Live
[TRANSLATED MESSAGE]
A Russian military medic who handed over a Russian Defense Ministry base to journalists has been hospitalized in France
Alexei Zhilyaev defected from the war in Ukraine and disclosed to Radio Liberty journalists a Russian Defense Ministry database with data on 166,000 wounded Russian soldiers.
The man was found in hospital after several months without communication. Doctors assess his condition as serious: he has lost his memory and can't walk. At the same time, possible poisoning has been ruled out.
Zhilyaev went to war in November 2023, and nine months later he deserted. He escaped to France with the help of the "Go Wood" project. According to coordinators, he had severe PTSD.
After the publication of the Russian Defense Ministry database, Zhilyaev gave several interviews to Western media before disappearing. Now his condition raises serious suspicions among human rights activists.
@nexta_live
t.me/nexta_live/105195 ↩ ЛС: новини Львів
ЛС: новини Львів
[TRANSLATED MESSAGE]
❗️ The average pension in Lviv region is UAH 5.9 thousand, - LS infographic: Lviv news
The highest average pension is in Kyiv - UAH 8.8 thousand. Pensions are also high in Dnipropetrovs'k region - UAH 7.2 thousand, Donetsk region - UAH 7.9 thousand, and Luhansk region - UAH 7.4 thousand.
Meanwhile, the lowest average pensions are in western Ukraine: in Ternopil (5 thousand), Bukovyna (5.2 thousand), and Zakarpattia (5.2 thousand UAH).
Send us photos/videos/information ➡️ @lviv24x7_bot
🇺🇦 LS: Lviv news
t.me/c/1687769706/45025 ↩ Obozrevatel.ua
Obozrevatel.ua
[TRANSLATED MESSAGE]
‼️ Electricity prices for households remain unchanged this winter, - Yulia Svyrydenko
The government has extended the PSO for electricity until April 30, 2026. This means that during the heating season, citizens will continue to pay UAH 4.32
per kWh. Read more.
t.me/uaobozrevatel/193252 ↩ Ukraine NOW
Ukraine NOW
[TRANSLATED MESSAGE]
Electricity prices for households remain unchanged this winter, - Svyrydenko
The government has extended the PSO for electricity until April 30, 2026. This means that citizens will continue to pay UAH 4.32 per kWh during the heating season.
We also maintain a preferential price for consumers with electric heating. Thus, for consumption up to 2,000 kWh per month, the price will be UAH 2.64 per kWh, and for consumption above the established limit, the price will be UAH 4.32 per kWh," the Prime Minister of Ukraine said.
✅ We are on WhatsApp | Viber | Telegram
t.me/UkraineNow/76021 ↩ Оперативний ЗСУ
Оперативний ЗСУ
[TRANSLATED MESSAGE]
Putin, itogi
https://t.me/operativnoZSU/
t.me/operativnoZSU/194948 ↩ Оперативний ЗСУ
Оперативний ЗСУ
t.me/operativnoZSU/194949 ↩ Obozrevatel.ua
Obozrevatel.ua
t.me/uaobozrevatel/193251 ↩ Труха⚡️Україна
Труха⚡️Україна
[TRANSLATED MESSAGE]
👀 A miracle pill for weight loss without serious side effects has been created by British scientists - Bristolbrc.
This is a hydrogel-based drug without potent chemicals. substances. The pill expands in the stomach, creating a feeling of satiety and helping to reduce the amount of food consumed. Scientists plan to test Sirona in the UK and the US. If successful, it could be launched on the market in 2027.
ТРУХА⚡️Україна | Send news
t.me/c/1199360700/124196 ↩ Труха⚡️Україна
Труха⚡️Україна
t.me/c/1199360700/124198 ↩ Труха⚡️Україна
Труха⚡️Україна
t.me/c/1199360700/124197 ↩ Реальна Війна | Україна | Новини
Реальна Війна | Україна | Новини
[TRANSLATED MESSAGE]
Massacre of lawyers: NABU prohibits them from communicating with the media and continues illegal pressure
Kyiv lawyers who were wiretapped by the NABU in 2023 claim that the Bureau's management prohibits them from talking about the case in the media. The NABU's investigation against lawyers is turning into a protracted saga due to violations of jurisdiction and attempts to artificially leave the proceedings with the NABU, SAPO, and HACC. Suspicions are served randomly. And the ban on commenting on cases in the media is completely absurd.
As, in fact, is everything that is happening in this case. The NABU is trying to impose a political overtone on society, knowing in advance that it will lose in court.
Instead, detectives leak distorted information to friendly media outlets that "mirror" the investigation's version. Lawyers prepare lawsuits against such media.
Interestingly, the NABU detectives' versions are based on audio recordings from wiretaps that were illegal. The equipment was found by the lawyers themselves - in their own office, in the meeting room where they were talking to clients under investigation by the NABU.
The detectives seized some of the media without a court order, and some of them were received "from unidentified persons" after a long time. This means that the recordings cannot be considered reliable evidence without an expert examination.
"This case is proof that the leadership of the SAPO and the NABU is forcing their subordinates to engage in political reprisals. We, the lawyers to whom NABU and SAPO have lost most of their cases, have now become their target. Instead of fighting corruption, they have focused on political persecution and orders in a competitive environment," the bar association said.
As a reminder, in 2023, the NABU installed wiretapping in the office of Kyiv lawyers. The equipment was installed in a room for negotiations with clients who are under investigation by the bureau itself. The National Bar Association of Ukraine called such actions a gross violation of attorney-client privilege. The European Court of Human Rights has already accepted applications from eight lawyers whose rights were violated by the NABU.
🇺🇦Реальна War | Subscribe
t.me/voynareal/124480 ↩ NEXTA Live
NEXTA Live
[TRANSLATED MESSAGE]
Archaeologists sound the alarm: Tutankhamun's tomb is in danger of collapse
Cairo University scientists have discovered deep cracks in the stone blocks of Pharaoh Tutankhamun's tomb.
According to the study, the cracks run through the ceiling of the entrance and burial chambers, causing water to seep inside.
The moisture destroys the rock and also causes fungus and flaking of the frescoes.
"If not intervened urgently, the structural integrity of the tomb could be lost forever," Professor Syed Hemada told the Daily Mail.
The main cause of the destruction is the 1994 flood, after which the walls and ceiling began to weaken. Now the degradation processes have accelerated.
According to archaeologists' forecasts, the ancient burial site may collapse at any moment.
At the same time, the Ministry of Tourism and Antiquities of Egypt rejected the conclusions of scientists.
@nexta_live
t.me/nexta_live/105192 ↩ NEXTA Live
NEXTA Live
t.me/nexta_live/105194 ↩ NEXTA Live
NEXTA Live
t.me/nexta_live/105193 ↩ Инсайдер Киев
Инсайдер Киев
[TRANSLATED MESSAGE]
❗️Киевская area. Schedules for tomorrow
Insider Kiev
t.me/KyivPolitic/56121 ↩ Инсайдер Киев
Инсайдер Киев
t.me/KyivPolitic/56122 ↩ Ukraine NOW
Ukraine NOW
[TRANSLATED MESSAGE]
Meanwhile, the number of people injured in the strike on the kindergarten has increased to ten
Among them is a five-year-old girl," said Mayor Ihor Terekhov.
t.me/UkraineNow/76020 ↩ STERNENKO
STERNENKO
[TRANSLATED MESSAGE]
The third plant connected to Russian oil is on fire in the EU: a fire broke out in Bratislava at a refinery owned by the Hungarian company MOL.
t.me/ssternenko/50982 ↩ STERNENKO
STERNENKO
t.me/ssternenko/50983 ↩ Оперативний ЗСУ
Оперативний ЗСУ
[TRANSLATED MESSAGE]
👀 In Bratislava, an oil refinery owned by the Hungarian MOL, which processes Katsap oil supplied through the Druzhba pipeline, is on fire
👀https://t.me/operativnoZSU/
t.me/operativnoZSU/194946 ↩ Оперативний ЗСУ
Оперативний ЗСУ
t.me/operativnoZSU/194947 ↩ Obozrevatel.ua
Obozrevatel.ua
[TRANSLATED MESSAGE]
🔥 A refinery processing Russian oil is on fire in Bratislava
The refinery is said to be owned by the Hungarian company MOL and processes raw materials supplied by the Druzhba pipeline.
t.me/uaobozrevatel/193248 ↩ Obozrevatel.ua
Obozrevatel.ua
t.me/uaobozrevatel/193249 ↩ INSIDER UA
INSIDER UA
[TRANSLATED MESSAGE]
Ozempic all? Scientists have created new weight loss pills that have no side effects and have shown success in clinical trials - Bristolbrc
The drug, Sirona, is a hydrogel-based tablet that expands in the stomach and induces a feeling of satiety.
The peculiarity of the drug is that it contains neither hormones nor active chemical components, due to which it is theoretically considered safer than the popular Ozempic.
Subscribe to INSIDER UA | Submit content
t.me/insiderUKR/109501 ↩ InformNapalm
InformNapalm
[TRANSLATED MESSAGE]
🇸🇪 We thank Sweden for its consistent support of Ukraine.
And we would like to thank Thule, a volunteer editor of the Swedish version of the international community's InformNapalm website, who has been tirelessly translating all our research on the facts of Russian aggression since 2015. We are sure that the role of this volunteer in conveying important facts to the Swedish audience cannot be overestimated. And it is the hard work of people of good will like Thule that makes up the path that brings Ukraine closer to victory.
Thank you!
t.me/informnapalm/25999 ↩ Ukraine NOW
Ukraine NOW
[TRANSLATED MESSAGE]
Fraudsters raise money to restore a kindergarten damaged in Kharkiv during the October 22 attack
No official collection was announced - these are fake accounts created for profit, the kindergarten said.
"Do not transfer money to dubious cards and check information on official resources!" reports the Center for Strategic Communications and Information Security.
t.me/UkraineNow/76019 ↩ Труха⚡️Україна
Труха⚡️Україна
[TRANSLATED MESSAGE]
Poltava region is reaching a new level of international cooperation!
Volodymyr Kohut, the head of the Poltava Regional Government, together with representatives of the Poltava Business Association, paid an important working visit to the UK. Kohut and his team held talks with the Ambassador of Ukraine to the UK, Valeriy Zaluzhnyi, to discuss strengthening Poltava's partnership with British regions, developing economic cooperation, and attracting investment to the region.
During the trip, the delegation studied the best British practices in clean energy and waste management, areas that are key to the region's sustainable development today.
ТРУХА⚡️Україна | Send news
t.me/c/1199360700/124195 ↩ Реальна Війна | Україна | Новини
Реальна Війна | Україна | Новини
[TRANSLATED MESSAGE]
😎 The third oil facility is on fire in Eastern Europe, and it is also in "connection" with Russia - this time in Bratislava, a refinery owned by Hungary's MOL is on fire, processing Russian oil coming through the Druzhba pipeline.
🇺🇦Реальна War | Subscribe
t.me/voynareal/124478 ↩ Реальна Війна | Україна | Новини
Реальна Війна | Україна | Новини
t.me/voynareal/124479 ↩ INSIDER UA
INSIDER UA
[TRANSLATED MESSAGE]
⚡️В A refinery owned by Hungary's MOL, which processes Russian oil coming through the Druzhba pipeline, is on fire in Bratislava
Subscribe to INSIDER UA | Submit content
t.me/insiderUKR/109499 ↩ INSIDER UA
INSIDER UA
t.me/insiderUKR/109500 ↩ Україна 24/7 - новини
Україна 24/7 - новини
[TRANSLATED MESSAGE]
🔥 An oil refinery owned by Hungary's MOL, which processes Russian oil coming through the Druzhba pipeline, is on fire in Bratislava.
Ukraine 24/7
t.me/ukraina_novosti/101674 ↩ Україна 24/7 - новини
Україна 24/7 - новини
t.me/ukraina_novosti/101675 ↩ Obozrevatel.ua
Obozrevatel.ua
[TRANSLATED MESSAGE]
New blackouts will affect almost everyone: Ukrainians received an important warning from the energy sector
On October 23, stabilization blackouts will continue in most regions of Ukraine. They will last almost the entire day.
This was reported by Ukrenergo. Read more.
t.me/uaobozrevatel/193246 ↩ NEXTA Live
NEXTA Live
[TRANSLATED MESSAGE]
Small business in Russia on the verge of disaster: one third of companies may close due to the new tax reforms
Starting from 2026, a tax reform will come into force in Russia, which the authorities explain by "the need to mobilize resources in war conditions".
Now even small businesses will be obliged to pay VAT. Previously, they worked under a simplified system without this tax.
According to business associations, about 700 thousand entrepreneurs will be hit. This is one in ten in the country.
Almost a third of them have already announced that they will close their business, and another 30% plan to go into the "shadow" or use gray schemes.
According to the Ministry of Economic Development, 96% of all companies in Russia are microbusinesses with income up to 13 million rubles a year. For them, the new taxes will become an unbearable burden.
@nexta_live
t.me/nexta_live/105191 ↩ ЛС: новини Львів
ЛС: новини Львів
[TRANSLATED MESSAGE]
Lviv City Council begins to repay debts of prosthetic plant
Lviv city council has started paying off the first UAH 10 million of the Lviv Prosthetic Plant's debts. Initially, the funds were used to pay off the outstanding salaries to employees.
The company's total debt is about UAH 70 million. The city council notes that the repayment will take place in stages and plans to fully pay off the debt by 2028.
Send us photos/videos/information ➡️ @lviv24x7_bot
🇺🇦 LS: Lviv news
t.me/c/1687769706/45024 ↩ Труха⚡️Україна
Труха⚡️Україна
[TRANSLATED MESSAGE]
WE CAN NO LONGER REMAIN SILENT 😱😱😱
🍏 MyCredit GIVES A NEW iPhone 15 👉 t.me/MyCreditua
Already on 31.10, we will select a lucky winner who will receive a new smartphone 📲
✅ The rules are very simple:
1. Become a MyCredit client
2. Take out a first or repeat loan, or apply for an extension and automatically become a participant in the drawing
🙀 Make your dream of a new phone come true!
GO 👇👇👇
https://mycrd.it/tm
https://mycrd.it/tm
https://mycrd.it/tm
The maximum amount is up to UAH 35,000 for repeat customers;
Loan term - up to 30 days;
Real annual interest rate - up to 6030.74%;
Essential characteristics of the service
Warning about possible consequences
Official rules of the promotion
#advertising
t.me/c/1199360700/124194 ↩ Ukraine NOW
Ukraine NOW
[TRANSLATED MESSAGE]
Minister of the Interior of the German state of Thuringia suspects the AfD of collecting intelligence for Russia
Georg Mayer believes that members of the far-right Alternative for Germany are abusing their right to request information that may be of interest to Russia.
"It seems that the AfD is working according to the Kremlin's order list with its requests," he said.
Mayer added that in Thuringia alone, the AfD has sent 47 such requests in the past twelve months, with "increasing frequency and depth of detail." The requests relate to, among other things, critical infrastructure and means of countering drones.
t.me/UkraineNow/76018 ↩ Obozrevatel.ua
Obozrevatel.ua
[TRANSLATED MESSAGE]
"It doesn't matter to Putin whether a country is in NATO or not." Zelensky reminds that the whole of Europe is at risk
"Europe will have risks. I think Sweden is a very important part of the EU, a strong part. And of course, if one of the European countries is at risk, then the whole of Europe is at risk. That's all. I have been talking about this, if we do not stop Putin, if we do not have a plan to come to peace, if we do not have a minimum ceasefire to understand what to do next, the next steps, Putin will try to open a new front,"
- said the President of Ukraine.
Read more
t.me/uaobozrevatel/193245 ↩ Obozrevatel.ua
Obozrevatel.ua
[TRANSLATED MESSAGE]
Some vacancies are planned to be filled by foreigners: what the Ukrainian labor market expects
Ukraine's labor market is entering a difficult period, with mobilization, emigration, and staff shortages increasing the risk of shadowing, and some vacancies are planned to be filled by labor migrants from Asia and the Caucasus. Despite this, the state has already created more than 45,000 official jobs and issued grants worth UAH 8 billion. Read more.
t.me/uaobozrevatel/193244 ↩ Україна 24/7 - новини
Україна 24/7 - новини
[TRANSLATED MESSAGE]
❗️Цены electricity prices for residential customers remain unchanged until April 30, 2026 - Premier Sviridenko.
Ukraine 24/7
t.me/ukraina_novosti/101673 ↩ STERNENKO
STERNENKO
[TRANSLATED MESSAGE]
The EU court has lifted sanctions against Russian billionaire Mikhail Gutseriev, who is close to Lukashenko.
The sanctions were extended in February 2024 due to Belarus' support for Russian aggression against Ukraine, but the court found this decision to be unfounded.
Indeed, Belarus is just an aggressor country. It's just a Russian billionaire. We should give them a peace prize.
t.me/ssternenko/50977 ↩ Оперативний ЗСУ
Оперативний ЗСУ
[TRANSLATED MESSAGE]
In Kramatorsk, Russian 3.14 daras struck a windmill - city council
https://t.me/operativnoZSU/
t.me/operativnoZSU/194944 ↩ Ukraine NOW
Ukraine NOW
[TRANSLATED MESSAGE]
Hungarian Foreign Minister Peter Szijjarto criticizes Radoslaw Sikorski's statement about Putin's possible arrest if his plane flies over Poland
In response, Polish Foreign Minister Sikorski said: "I hope that your brave countryman, Major 'Magyar' (Ukraine's Security Service Commander Robert 'Magyar' Brovdi), will finally be able to disable the oil pipeline that feeds Putin's military machine, and you will receive your oil through Croatia."
✅ We are on WhatsApp | Viber | Telegram
t.me/UkraineNow/76017 ↩ NEXTA Live
NEXTA Live
[TRANSLATED MESSAGE]
Africa is a teenager, Europe is a pensioner: a map of the median age of the world's peoples has appeared
According to Visual Capitalist and the CIA, the median age of the world's population is 30.9 years. But the distribution is extremely uneven.
Africa is the youngest region: in 21 countries, including Niger (15.2 years), Uganda, Angola, Mali and Chad, the median age does not exceed 20 years. This means that half of the population there are adolescents.
At the other pole are aging Europe and East Asia. The "oldest" countries in the world include Monaco (57 years), Japan (almost 50), St. Pierre and Miquelon, Italy and Germany.
In Asia, they are joined by Hong Kong and South Korea: the aging rate here is one of the highest in the world.
The world is aging, but unevenly. Some are getting younger, while others are rapidly losing demographic stability.
@nexta_live
t.me/nexta_live/105189 ↩ Obozrevatel.ua
Obozrevatel.ua
[TRANSLATED MESSAGE]
Russian agent was preparing assassination attempts on Odesa activists Hanul and Beibutian: in Odesa, he was sentenced to imprisonment
On October 22, the Prymorskyi District Court of Odesa announced the verdict against Mykola Mayorenko, accused of organizing the contract killing of two civil society activists, Gennadiy Beibutyan and Demyan Hanul. The court sentenced him to 14 years in prison with confiscation of property. Read more.
t.me/uaobozrevatel/193243 ↩ Инсайдер Киев
Инсайдер Киев
[TRANSLATED MESSAGE]
Some residents of Kiev have received messages from DTEK that they plan to cut off light from 20.00 to 3.00 at night.
Kiev insider
t.me/KyivPolitic/56120 ↩ Реальна Війна | Україна | Новини
Реальна Війна | Україна | Новини
[TRANSLATED MESSAGE]
❗️Росія today dropped X-22/32 cruise missiles from two sides - the planes took off from the Olenya airfield and the drop took place within the Barents Sea.
Each Tu-22M3 has 1 X-22/32 cruise missile on board.
At present, there are at least 9 Tu-22M3s ready for combat missions, including the Shaykovka airfield.
🇺🇦Реальна War | Subscribe
t.me/voynareal/124475 ↩ Реальна Війна | Україна | Новини
Реальна Війна | Україна | Новини
t.me/voynareal/124476 ↩ Реальна Війна | Україна | Новини
Реальна Війна | Україна | Новини
t.me/voynareal/124477 ↩ ЛС: новини Львів
ЛС: новини Львів
[TRANSLATED MESSAGE]
🚱 Water will be cut off for a day in Ryasne, Levandivka and some parts of three districts of Lviv.
Emergency repairs will be carried out on the water supply system. Water will be cut off from 5:00 a.m. on October 23 to 6:00 a.m. on October 24. This also applies to Rudne, Ryasne-Ruska, Pidryasne, Domazhyr and more than 10 other villages.
In Lviv, Ryasne-1, Ryasne-2, Levandivka and parts of Shevchenkivskyi, Frankivskyi and Zaliznychnyi districts will be without water.
Send us photos/videos/information ➡️ @lviv24x7_bot
🇺🇦 LS: Lviv news
t.me/c/1687769706/45020 ↩ ЛС: новини Львів
ЛС: новини Львів
t.me/c/1687769706/45021 ↩ ЛС: новини Львів
ЛС: новини Львів
t.me/c/1687769706/45022 ↩ Оперативний ЗСУ
Оперативний ЗСУ
[TRANSLATED MESSAGE]
Electricity prices for households remain unchanged this winter.
The government has extended the PSO for electricity until April 30, 2026. This means that citizens will continue to pay UAH 4.32 per kWh during the heating season.
↪SO__1FAE1↩https://t.me/operativnoZSU/
t.me/operativnoZSU/194943 ↩ INSIDER UA
INSIDER UA
[TRANSLATED MESSAGE]
Electricity prices for households remain unchanged until April 30, 2026 - Prime Minister Iulia Sviridenko
During the heating season, citizens will continue to pay UAH 4.32 per kWh.
Subscribe to INSIDER UA | Send content
t.me/insiderUKR/109498 ↩ NEXTA Live
NEXTA Live
[TRANSLATED MESSAGE]
Chronicles of the imperial hinterland: a disabled woman and her two children live in a rotten house after flooding
Galina, 58, and her children survive in a warped house on the outskirts of Tulun (Irkutsk Region).
After the 2019 flood, the building gave a lurch, the beams rotted, and the floor fell through. In 2020, the house was recognized as an emergency, but they were never given new housing.
The house has no running water or sewage, the toilet is outside. Water is ordered at an impressive price and carried in buckets.
The authorities reject them and tell them to do their own repairs.
On the other hand, the Russian state is doing well in financing its war of aggression.
@nexta_live
t.me/nexta_live/105188 ↩ МВС України
МВС України
[TRANSLATED MESSAGE]
Defense procurement in the National Guard is getting an additional format.
Together with the Ministry of Defense, we are launching a pilot project: procurement for the National Guard through the Defense Procurement Agency's DOT-Chain digital system.
This means:
- military units can independently choose UAV and EW models that are in the system and have been verified by the Defense Procurement Agency;
- fast contracts - quick deliveries directly to the combat units of the NGU;
- full transparency and absence of unnecessary bureaucracy.
We are updating the procurement system so that the units receive what they need without delays and unnecessary chains.
t.me/mvs_ukraine/55311 ↩ Obozrevatel.ua
Obozrevatel.ua
[TRANSLATED MESSAGE]
Where to see power outage schedules and how to find your group: step-by-step instructions
On October 22, Ukraine introduced schedules of stabilization power outages across the country. Regional power distribution companies have developed their own schedules and posted them on their websites. Read OBOZ.UA's article on how to find out where to see your schedule, how to read it correctly, and what to do if the energy company's website does not open.
t.me/uaobozrevatel/193241 ↩ InformNapalm
InformNapalm
[TRANSLATED MESSAGE]
Journalist Denis Kazansky drew attention to an excerpt from an interview with Maria Lvova-Belova, the Russian Presidential Commissioner for Children's Rights, who admits that she stole a child in Mariupol, and this is one of the reasons why an international arrest warrant has been issued for her.
In 2023, Ukrainian hackers reported hacking into the correspondence of Maria Lvova-Belova, her father, and her husband (now ex-husband, as she later married Russian "Orthodox oligarch" Malofeev, who has also sponsored hybrid operations to invade Donbas since 2014).
On March 17, 2023, the International Criminal Court issued arrest warrants for Putin and Lvova-Belova for organizing mass abductions of Ukrainian children from the temporarily occupied territories of Ukraine.
If all the countries that have ratified the Rome Statute fulfilled their obligations, Putin would not be able to visit and cross the airspace of 123 countries. Because international law no longer works in the world, but only the law of the strong.
Therefore, we must become strong so that no dictator can organize genocide of the Ukrainian people and steal Ukrainian children with impunity.
t.me/informnapalm/25998 ↩ INSIDER UA
INSIDER UA
[TRANSLATED MESSAGE]
⚡️Уже now it is obvious that this winter may turn out to be much more difficult than the previous one, - head of the subcommittee on energy security of the Verkhovna Rada Committee Victoria Hryb
"The most difficult situation is in frontline and border regions. Chernihiv, Sumy, Kharkiv, Kharkiv, Zaporizhzhya, Dnipropetrovsk, Mykolayiv, Odessa and Kherson regions are in the zone of the highest risk".
If the energy front falls - the consequences will be catastrophic for the whole country. The economy will not work, there will be no resources for our army, there will be no heat in homes, hospitals and schools.
Subscribe to INSIDER UA | Send content
t.me/insiderUKR/109497 ↩ Obozrevatel.ua
Obozrevatel.ua
[TRANSLATED MESSAGE]
Swedish JAS 39 Griffins: what kind of aircraft are they and how much can they strengthen Ukrainian skies?
On Wednesday, October 22, 2025, President of Ukraine Volodymyr Zelenskyy and Prime Minister of Sweden Ulf Kristersson signed a letter of intent on cooperation between the two countries in the development of air capabilities. This document paves the way for Ukraine to receive Swedish fourth-generation JAS 39 Gripen multi-role fighters.
OBOZ.UA decided to remind you what these planes are and how they can strengthen the Air Force of the Ukrainian Armed Forces.
t.me/uaobozrevatel/193240 ↩ Оперативний ЗСУ
Оперативний ЗСУ
[TRANSLATED MESSAGE]
14 years in prison: Mykola Mayorenko was found guilty of organizing the contract killing of civic activists Gennadiy Beibutyan and Demyan Hanul.
https://t.me/operativnoZSU/
t.me/operativnoZSU/194942 ↩ NEXTA Live
NEXTA Live
[TRANSLATED MESSAGE]
A child contracted gonorrhea after eating the contents of a lab cup
A unique case of gonorrhea infection has been recorded in the USA: a three-year-old boy from San Antonio contracted the infection after eating the contents of a petri dish.
His mother, a microbiology lab technician, accidentally left her son alone in the car with the samples.
While the woman was away, the child opened one of the cups containing what is known as "chocolate agar medium," a nutrient mixture for bacteria that resembles chocolate, and ate it.
Inside were live colonies of Neisseria gonorrhoeae, the causative agent of gonorrhea.
Eight days later, tests showed infection. The boy was treated with penicillin and made a full recovery.
@nexta_live
t.me/nexta_live/105187 ↩ Ukraine NOW
Ukraine NOW
[TRANSLATED MESSAGE]
On October 23, electricity consumption will be limited in most regions of Ukraine
From 7:00 to 23:00, hourly outage schedules for up to three simultaneous outages will be in effect for household consumers, and power limitation schedules for industrial consumers, Ukrenergo said.
✅ We are on WhatsApp | Viber | Telegram
t.me/UkraineNow/76016 ↩ Труха⚡️Україна
Труха⚡️Україна
[TRANSLATED MESSAGE]
❤️🩹 The former head of the Kharkiv region's State Emergency Service, General Volobuyev, rescued children from a kindergarten in Kharkiv that was under attack by Russians.
🫡❤️
ТРУХА⚡️Україна | Send news
t.me/c/1199360700/124191 ↩ INSIDER UA
INSIDER UA
[TRANSLATED MESSAGE]
The court passed a verdict on the case of attempted assassination of public activists Gennady Beybutyan and Demyan Ganul.
Nikolai Mayorenko was found guilty and sentenced to 14 years of imprisonment with confiscation of property.
Subscribe to INSIDER UA | Send content
t.me/insiderUKR/109496 ↩ Ukraine NOW
Ukraine NOW
[TRANSLATED MESSAGE]
Russia is putting pressure on some European countries not to contribute to the PURL initiative, - Zelenskyy
"The PURL program is important. We know that Russia is working with some European countries, putting pressure on them not to contribute to this program. This program is mostly about PAC-3, because we need these missiles, especially during the war, especially for Patriot systems," the President of Ukraine emphasized.
✅ We are on WhatsApp | Viber | Telegram
t.me/UkraineNow/76015 ↩ Obozrevatel.ua
Obozrevatel.ua
[TRANSLATED MESSAGE]
Power outage schedules announced in Kyiv: what hours there will be no electricity
Due to the tense situation in the Ukrainian power grid after another shelling by Russia, Kyiv has introduced stabilization blackout schedules. Residents of the capital will be cut off from electricity in two stages for 5-6 hours.
The power will be cut off in three stages simultaneously, and the whole city may be without electricity for an hour. Read more.
t.me/uaobozrevatel/193239 ↩ ЛС: новини Львів
ЛС: новини Львів
[TRANSLATED MESSAGE]
⚖️ Gang gets suspended sentences for blackmailing men with intimate videos
A 29-year-old resident of Mykolaiv, Lviv region, and her two accomplices who extorted money from men by threatening to publish compromising videos were tried in Uzhhorod.
The scheme was simple: the woman would meet men, invite them to her home, and use a hidden camera to record intimate moments. After that, the accomplices would demand money, blackmailing them into distributing the recordings.
The court found the organizer guilty and sentenced her to three years in prison, but commuted her sentence to a suspended term of one year and two months. One of the accomplices received the same sentence, but a year's suspended sentence, and the third was released due to lack of evidence.
Send us photos/videos/information ➡️ @lviv24x7_bot
🇺🇦 LS: Lviv news
t.me/c/1687769706/45019 ↩ INSIDER UA
INSIDER UA
[TRANSLATED MESSAGE]
Ukrainian men of 18-22 years old leave for Germany en masse - Barrons
The number of Ukrainians aged 18-22 seeking asylum in Germany increased more than 10 times in early October compared to the situation before August 26, when the rules on traveling abroad were relaxed.
Subscribe to INSIDER UA | Submit content
t.me/insiderUKR/109495 ↩ Реальна Війна | Україна | Новини
Реальна Війна | Україна | Новини
t.me/voynareal/124473 ↩ Obozrevatel.ua
Obozrevatel.ua
[TRANSLATED MESSAGE]
👀 Ukrainians will receive UAH 20 thousand for the winter
In the frontline communities of Sumy region, 800 families (about 1760 people) will receive winterization assistance. The payments will amount to UAH 19,400 in cash or 3.42 tons of briquettes with delivery to ensure warmth and safety during the cold weather. Read more.
t.me/uaobozrevatel/193238 ↩ Ukraine NOW
Ukraine NOW
[TRANSLATED MESSAGE]
Russian military drops explosives from a drone on an 84-year-old woman grazing a goat in Kherson region
In Antonivka, Russians dropped explosives from a UAV on an 84-year-old woman who was on the street. She died on the spot as a result of the attack, law enforcement officials said.
"In September, she said that her house was destroyed by the occupiers, but she refused to leave because she had to take care of 20 goats.
t.me/UkraineNow/76014 ↩ Україна 24/7 - новини
Україна 24/7 - новини
[TRANSLATED MESSAGE]
❗️Есть there is a very big risk that there will not be enough gas as early as December-January. So far, indeed, the heating season is under a big question mark," MP Bondar said.
Ukraine 24/7
t.me/ukraina_novosti/101670 ↩ StopFake
StopFake
[TRANSLATED MESSAGE]
‼ Social media users are spreading information that the French police have allegedly detained two Ukrainian refugees for robbing the Louvre. The news is accompanied by photos showing the two detainees, who are allegedly involved in the robbery that took place on October 19, 2025, in the Parisian museum. Nine jewels from the so-called Napoleon collection were stolen.
✅ In fact, this information is fake, using real photos, but on another note, the incident took place in Poland and involved an attempted theft of a tractor: https://fmm.io/12Oy
t.me/StopFake/6216 ↩ Труха⚡️Україна
Труха⚡️Україна
t.me/c/1199360700/124189 ↩ Реальна Війна | Україна | Новини
Реальна Війна | Україна | Новини
[TRANSLATED MESSAGE]
Akhmetov's Metinvest is among Ukraine's top 50 employers: the company relies on veterans and Ukrainian personnel
Metinvest Group has been ranked among Ukraine's top 50 employers by NV and Odgers. The company was recognized for its support of employees during the war, veterans' reintegration programs and personnel development.
According to Yuriy Ryzhenkov, CEO of the Group, the main staffing challenge in the steel industry is the shortage of personnel: the company currently has about 4,000 vacancies and more than 8,000 employees have been mobilized. About 1,000 veterans are already working at the enterprises, and training, mentoring and psychological support programs have been created for them.
Since the beginning of the war, Metinvest has increased salaries by an average of 50%, and in 2024, by another 15-30% depending on the profession. The company is developing educational programs for young people and women, including through Metinvest Polytechnic University, which has already graduated more than 260 specialists.
"Veterans are our largest talent pool. But even with the shortage, we are confident that we will be able to fill the vacancies with Ukrainians," says Ryzhenkov.
🇺🇦Реальна War | Subscribe
t.me/voynareal/124471 ↩ INSIDER UA
INSIDER UA
[TRANSLATED MESSAGE]
The Swedish embassy reacted with memes to the news of the Gripen supply agreement signing
Subscribe to INSIDER UA | Submit content
t.me/insiderUKR/109493 ↩ INSIDER UA
INSIDER UA
t.me/insiderUKR/109494 ↩ Реальна Війна | Україна | Новини
Реальна Війна | Україна | Новини
[TRANSLATED MESSAGE]
Witness in the case of NABU detective Magamedrasulov is being served with a notice of suspicion for lying in court: examinations conducted
A witness in the case of NABU detective Ruslan Magamedrasulov will soon be served with a suspicion for giving false testimony under oath in court. It is about Yusuf Mameshev, who voiced false information to help the NABU detective avoid criminal liability. The prosecution has already conducted a number of forensic examinations that confirm the falsity of the witness's testimony.
- In court, Mameshev assures that he discussed with Magamedrasulov the supply of technical hemp to Uzbekistan. However, the investigation has already conducted three forensic phonoscopic examinations, which show that the recording of their conversation refers to the Republic of Dagestan. This is a subject of the Russian Federation with which Ukraine has banned trade;
- The investigation has official documents approved by the Ministry of Agrarian Policy of Ukraine, which confirm that there is no state program for growing technical hemp in Uzbekistan. But such a program is in place in Dagestan;
- A psychological examination showed that Mameshev was confused in his testimony and tried to conceal certain circumstances of the case;
- Mameshev has relatives in Dagestan, but refused to explain what they do;
- Recently, Mameshev was detained by the TCC, but after an unknown call, NABU officers arrived at the scene and forcibly took him away, calling him a "valuable witness."
The prosecution is convinced that the defense witness did not provide any legal evidence of his words. Therefore, all of his testimony is regarded as subjective statements that are deliberately false and misleading to the court and society.
🇺🇦Реальна War | Subscribe
t.me/voynareal/124470 ↩ Україна 24/7 - новини
Україна 24/7 - новини
[TRANSLATED MESSAGE]
Witness in the case of NABU detective Magamedrasulov will receive suspicion for lying under oath: expert examinations conducted
A witness in the case of NABU detective Ruslan Magamedrasulov will soon receive suspicion for giving false testimony under oath in court. We are talking about Yusuf Mameshev, who voiced false information to help the NABU detective to avoid criminal liability. The prosecution has already conducted a number of forensic examinations that confirm the falsity of the witness's testimony.
- Mameshev assures in court that he discussed with Magamedrasulov the supply of technical hemp to Uzbekistan. Although the investigation already has three forensic phonoscopic examinations, which testify that the recording of their conversation refers specifically to the Republic of Dagestan. This is a subject of the Russian Federation, with which Ukraine has banned trade;
- The investigation has official documents approved by the Ukrainian Ministry of Agrarian Policy, which confirm that there is no state program for growing industrial hemp in Uzbekistan. But there is such a program in Dagestan;
- Psychological expertise showed that Mameshev was confused in his testimony and tried to conceal certain circumstances of the case;
- Mameshev has relatives in Dagestan but refused to explain what they do;
- Mameshev was recently detained by the TCC, but after a call from unknown persons, NABU officers arrived at the place and forcibly took him away from there, calling him a "valuable witness".
The prosecution is convinced that the witness of the defense side did not provide any legal evidence of his words. Therefore, all his testimony is regarded as subjective statements that are knowingly false and misleading the court and society.
Ukraine 24/7
t.me/ukraina_novosti/101669 ↩ Obozrevatel.ua
Obozrevatel.ua
[TRANSLATED MESSAGE]
The Swedish Embassy reacted to the news of the agreement with a funny meme about a cat and Gripen 😼
What would it mean? 🤔
Details
t.me/uaobozrevatel/193237 ↩ NEXTA Live
NEXTA Live
t.me/nexta_live/105184 ↩ STERNENKO
STERNENKO
[TRANSLATED MESSAGE]
Tomorrow, electricity consumption will be restricted in most regions of Ukraine from 07:00 to 23:00, Ukrenergo.
For household consumers - hourly outages (up to three queues simultaneously).
For industrial consumers - power restrictions.
t.me/ssternenko/50973 ↩ Obozrevatel.ua
Obozrevatel.ua
[TRANSLATED MESSAGE]
💡 Tomorrow, October 23, power outage schedules will be in effect throughout the day in most regions of Ukraine
From 07:00 to 23:00, consumption restriction measures will be enforced:
For household consumers - schedules of hourly outages (HOU) with up to three queues simultaneously
For industrial consumers - power limitation schedules
t.me/uaobozrevatel/193236 ↩ Україна 24/7 - новини
Україна 24/7 - новини
[TRANSLATED MESSAGE]
❗️Завтра in most regions of Ukraine from 07:00 to 23:00 will be forced to apply schedules of light outages - up to three queues at the same time - Ukrenergo.
Ukraine 24/7
t.me/ukraina_novosti/101668 ↩ Оперативний ЗСУ
Оперативний ЗСУ
[TRANSLATED MESSAGE]
Tomorrow, from 07:00 to 23:00, power outage schedules will be in effect - Ukrenergo
For household consumers - schedules of hourly outages of up to three stages simultaneously
For industrial consumers - power limitation schedules
↪SO__1FAE1↩https://t.me/operativnoZSU/
t.me/operativnoZSU/194940 ↩ Реальна Війна | Україна | Новини
Реальна Війна | Україна | Новини
[TRANSLATED MESSAGE]
❗️Завтра almost all over Ukraine from 07:00 to 23:00 hourly outage schedules (HOS) with up to three queues simultaneously will be applied - Ukrenergo
🇺🇦Реальна War | Subscribe
t.me/voynareal/124469 ↩ Инсайдер Киев
Инсайдер Киев
[TRANSLATED MESSAGE]
❗️Завтра light outage schedules will be forced in most regions of Ukraine from 07:00 to 23:00 - Ukrenergo
For household consumers - there will be schedules of hourly blackouts of up to three queues at a time.
Insider Kiev
t.me/KyivPolitic/56119 ↩ INSIDER UA
INSIDER UA
[TRANSLATED MESSAGE]
❗️Завтра in most regions of Ukraine from 07:00 to 23:00 will be forced to apply measures to limit consumption - Ukrenergo
For household consumers - there will be schedules of hourly disconnections of up to three queues at a time.
Subscribe to INSIDER UA | Send content
t.me/insiderUKR/109492 ↩ ЛС: новини Львів
ЛС: новини Львів
[TRANSLATED MESSAGE]
🚑 Regional hospital became part of the University hospital - Danylo Halytskyi Lviv National Medical University
As part of the merger, it is planned to involve the scientific and pedagogical staff of clinical departments in providing medical care to patients and to actively involve the staff of the hospital departments in teaching.
All the employees of the LOCL have written applications for transfer and today have become employees of the University Hospital.
Send us photos/videos/information ➡️ @lviv24x7_bot
🇺🇦 LS: Lviv news
t.me/c/1687769706/45018 ↩ Труха⚡️Україна
Труха⚡️Україна
[TRANSLATED MESSAGE]
❗️УВАГА! INFORMATION ABOUT THE OUTAGE
Tomorrow, OCTOBER 23, in most regions of Ukraine, from 07:00 to 23:00, consumption restrictions will be enforced
For household consumers - hourly outage schedules (HOS) for up to three queues simultaneously
ТРУХА⚡️Україна | Send news
t.me/c/1199360700/124185 ↩ Аеророзвідка | Aerorozvidka
Аеророзвідка | Aerorozvidka
[TRANSLATED MESSAGE]
In the face of threats, Ukrainian society demonstrates a unique ability to self-organize and mutually support each other💙💛 This became apparent in 2014 and has intensified since 2022.
It was civil society - volunteers, NGOs, and initiative communities - that took on a key role in supporting the army: from basic supplies to the creation of sophisticated technological solutions.
It is they who have driven the development of defense innovations, from the development of drones and robotic systems to the integration of artificial intelligence into military processes.
Today, new challenges are being added to the already known ones: massive attacks by the Shahed, the emergence of increasingly sophisticated electronic warfare, and the need to quickly update technological approaches.... When the cost of an attack drone is several thousand dollars, and its downing costs ten times more, there is a demand for effective and economically balanced solutions. Thus, the role of interceptors is growing.
📰 Read more about how volunteers, engineers and the state are jointly looking for these solutions in the article from the international publication Table Media: https://table.media/en/security/feature/ukraine-why-private-initiatives-rely-on-interceptor-drones
t.me/aerorozvidka/1809 ↩ INSIDER UA
INSIDER UA
[TRANSLATED MESSAGE]
Witness in the case of NABU detective Magamedrasulov prepared to be suspected for lying in court: expert examinations conducted
We are talking about Yusuf Mameshev, who voiced false information to help the NABU detective to avoid criminal liability. The prosecution has already conducted a number of forensic examinations, which confirm the falsity of the testimony of the witness.
▪️Мамешев assures in court that he discussed with Magamedrasulov the supply of technical cannabis to Uzbekistan. Although the investigation already has three forensic phonoscopic examinations that show that the recording of their conversation refers specifically to the Republic of Dagestan. This is a subject of the Russian Federation, with which Ukraine has banned trade;
▪️У investigators have official documents approved by the Ministry of Agrarian Policy of Ukraine, which confirm: there is no state program for growing technical hemp in Uzbekistan. But there is such a program in Dagestan;
▪️Психологическая examination showed that Mameshev was confused in his testimony and tried to hide certain circumstances of the case;
▪️Мамешев has relatives in Dagestan, but refused to explain what they do;
▪️Недавно Mameshev was detained by the TCC, but after a call from unknown persons, NABU officers came to the place and took him away from there by force, calling him a "valuable witness".
The prosecution is convinced that the witness of the defense side did not provide any legal evidence of his words. Therefore, all his testimony is regarded as subjective statements that are knowingly false and misleading the court and society.
Subscribe to INSIDER UA | Send content
t.me/insiderUKR/109491 ↩ Ukraine NOW
Ukraine NOW
[TRANSLATED MESSAGE]
Swedish defense company Saab AB agrees to jointly produce air defense systems in Ukraine
This was reported by the press service of the Ministry of Defense of Ukraine. Saab became a member of the Build in Ukraine initiative, a program aimed at attracting foreign defense companies to set up production facilities directly in Ukraine.
t.me/UkraineNow/76012 ↩ Реальна Війна | Україна | Новини
Реальна Війна | Україна | Новини
[TRANSLATED MESSAGE]
The third mental health center of the all-Ukrainian network POVERENNIA was opened in Poltava for military personnel, veterans and their families.
The Return was founded by Victor and Olena Pinchuk to support those who have experienced psychological trauma due to the war. Every year, more than 4,000 defenders and their families will be able to receive free assistance from a multidisciplinary team.
The center is equipped with a modern barrier-free space with rooms for individual and family therapy, a room for group sessions and a day hospital ward. The Poltava center meets the requirements of physical and psychological inclusiveness: everyone can seek help without fear of judgment or stigma, and an atmosphere of trust and respect for privacy is an integral part of the work of specialists.
👉 The RETURN Network provides free psychological assistance to the military, veterans and their families. The first stage involves opening 20-25 centers throughout Ukraine, which will be able to support more than 100,000 soldiers and their families annually.
🇺🇦Реальна War | Subscribe
t.me/voynareal/124464 ↩ Реальна Війна | Україна | Новини
Реальна Війна | Україна | Новини
t.me/voynareal/124467 ↩ Реальна Війна | Україна | Новини
Реальна Війна | Україна | Новини
t.me/voynareal/124466 ↩ Реальна Війна | Україна | Новини
Реальна Війна | Україна | Новини
t.me/voynareal/124468 ↩ Реальна Війна | Україна | Новини
Реальна Війна | Україна | Новини
t.me/voynareal/124465 ↩ Важные истории
Важные истории
[TRANSLATED MESSAGE]
A deserter who smuggled a database of Russian military hospitals abroad has been hospitalized in France with memory loss
🔵The former commander of the department of evacuation of the wounded and deserter Alexei Zhilyaev, who earlier handed over to journalists the database of the Ministry of Defense with records of hospitalized military, got into hospital and is in serious condition. This is reported by "Echo" with reference to a source.
Zhilyaev was hospitalized about two weeks ago, he can not walk and has lost his memory, notes the publication. It is not known what happened to him, but, according to the source of "Echo", doctors have ruled out a version of poisoning.
Before that, Zhilyaev had not been in touch for several months. His friends and acquaintances were looking for him, the source said.
🔵Alexei Zhilyaev went to war as a volunteer in late 2023, after he saw a group of disabled military men at the St. Petersburg train station, he himself told reporters. By education Zhilyaev was a medic and decided that he should use his skills at the front. At the same time, he emphasized in a conversation with Sever.Reality that he "has always been in opposition to this regime, going to Navalny's rallies."
🔵In February 2024, Zhilyaev was wounded, after which he spent a month and a half in the hospital and returned to the front. In August, he decided to desert, having realized "the pointlessness of the war itself" and his work there, he told reporters. After receiving an unofficial leave of absence, Zhilyaev made his way to France with the help of representatives of Go Wood. This was confirmed to Ekhu by Ivan Chuvilyaev, the project's spokesman.
"Not to say that the story was remarkable - rather, textbook. He accumulated debts, loans, he was just ashamed to talk about it openly, as I understand. Then he got into the evacuation group, he saw horrors, he had obvious PTSD, our psychologists worked with him," Chuvilyaev said.
🔵Zhilyaev took with him on a flash drive the database of the Main Military Medical Directorate of the Defense Ministry with records of 166,000 servicemen who passed through hospitals in Russia and annexed Crimea from January 2022 to June 2024. He handed the database to journalists of Radio Liberty.
👉 The publication shared part of this data with Important Stories. Having analyzed them together with other data on injuries and deaths of mobilized people, we told on the example of the Tomsk region how three years of mobilization affected thousands of Russian citizens who were forcibly sent to war.
Photo: "Sever.Realii"
YouTube | Telegram | X | Instagram
t.me/istories_media/10622 ↩ NEXTA Live
NEXTA Live
[TRANSLATED MESSAGE]
Serbia will not join the EU until it imposes sanctions against Russia
The European Parliament adopted a resolution to this effect today.
The European Parliament also condemned the actions of the Serbian authorities in suppressing protests after the Novi Sad tragedy.
Vucic will not be able to sit on two chairs, no matter how much he wants to. It is time to make a choice - either friendship with Russia or European integration.
We do not need another Trojan horse in the EU. Orban and Fitzo do not know what to do here.
@nexta_live
t.me/nexta_live/105182 ↩ ЛС: новини Львів
ЛС: новини Львів
[TRANSLATED MESSAGE]
Three illegal immigrants from Azerbaijan detained in Lviv region
During inspections by the Migration Police in Lviv region, three Azerbaijani citizens were found to be working at a construction site without legal grounds. They had violated the authorized period of stay in Ukraine.
The foreigners were taken to the migration service, where administrative reports were drawn up for violating migration laws. They face a fine of 3.4 to 5.1 thousand hryvnias.
The police also initiated a procedure for the men's forced return to their country of origin and a ban on entry to Ukraine.
Send us photos/videos/information ➡️ @lviv24x7_bot
🇺🇦 LS: Lviv news
t.me/c/1687769706/45017 ↩ Реальна Війна | Україна | Новини
Реальна Війна | Україна | Новини
[TRANSLATED MESSAGE]
⚠️Росія will launch the Oreshnik/RS-26 Rubizh from the Kapustyn Yar test site as part of nuclear exercises - according to the NOTAM, launches will take place from now until the end of October
Monitors note that during this period, air raids may be declared due to weapons activity at the test site.
🇺🇦Реальна War | Subscribe
t.me/voynareal/124463 ↩ Ukraine NOW
Ukraine NOW
[TRANSLATED MESSAGE]
Parliamentary provisional investigative commission to check whether Ternopil region leadership knew about actions of military suspected of torturing people
The commission wants to establish whether the head of the regional defense headquarters and the head of the regional military administration knew about these events, as there were regular meetings in the region with the participation of representatives of the TCC, said Mykhailo Tsymbalyuk, deputy head of the TSC.
The commission will also check, in particular, the initiative of the Ternopil TCC to involve combat units in the work, as well as the actions of law enforcement officers. As the MP emphasized, he does not know "a single regulatory document that allows this."
On October 15, Ternopil police detained seven soldiers suspected of kidnapping, torture, and extortion: the victims included both civilians and soldiers undergoing rehabilitation.
✅ We are on WhatsApp | Viber | Telegram
t.me/UkraineNow/76011 ↩ Obozrevatel.ua
Obozrevatel.ua
[TRANSLATED MESSAGE]
"It takes time": the Kremlin made a new statement about the Budapest summit
Peskov refused to name a timeframe for a possible meeting between Putin and Trump in Hungary.
"Actually, they (the dates - ed.) have not been determined, it is yet to be done. But this requires careful preparation, it takes time," the Kremlin spokesman said.
He also pretended that Moscow "did not hear" President Trump's statements the day before that he was not interested in "empty" meetings, which the US president said after a fruitless phone call between Secretary of State Marco Rubio and Russian Foreign Minister Lavrov.
Peskov called both this statement and Western media reports that the American side postponed the meeting because of Russia's unwillingness to make even the slightest concessions and refusal to cease fire in Ukraine "gossip" and "speculation."
Read more
t.me/uaobozrevatel/193233 ↩ NEXTA Live
NEXTA Live
[TRANSLATED MESSAGE]
Former Russian Deputy Defense Minister Timur Ivanov, sentenced to 13 years in prison for large-scale embezzlement, has asked to go to war as a stormtrooper.
In Russia, you can't be sure of jail or prison. Not long ago, Ivanov was drinking vodka with Peskov, and very soon he will go storming landings in the company of down-and-out convicts.
@nexta_live
t.me/nexta_live/105181 ↩ INSIDER UA
INSIDER UA
[TRANSLATED MESSAGE]
Telegram has gone down across Russia. Users complain that they cannot send messages and download media
Earlier, Roskomnadzor said it was partially restricting the work of WhatsApp and Telegram "to counter criminals."
The Iron Curtain is not far off.
Subscribe to INSIDER UA | Submit content
t.me/insiderUKR/109490 ↩ Труха⚡️Україна
Труха⚡️Україна
[TRANSLATED MESSAGE]
👀Telegram is down in almost all of Russia, it's down on phones and computers, and there are Russian channels.
What happened?
ТРУХА⚡️Україна | Send news
t.me/c/1199360700/124184 ↩ Ukraine NOW
Ukraine NOW
[TRANSLATED MESSAGE]
A few hours ago, Russian military opened fire on Kherson's Shipyard district
Apartment buildings, a shop, and communications were damaged. 7 people were wounded, - OVA.
✅ We are on WhatsApp | Viber | Telegram
t.me/UkraineNow/76010 ↩ Obozrevatel.ua
Obozrevatel.ua
[TRANSLATED MESSAGE]
Russia is not interested in peace: ISW explains why the Kremlin has relied on strikes on Ukraine's energy sector
Russia is stepping up air strikes on Ukraine's energy infrastructure. With winter approaching, Russians have started to hit energy facilities almost daily, and power outages are occurring in a number of regions.
These terrorist attacks aimed at plunging Ukrainians into darkness and cold once again confirm that Russia is not at all interested in ending the war.
Read more
t.me/uaobozrevatel/193232 ↩ Труха⚡️Україна
Труха⚡️Україна
[TRANSLATED MESSAGE]
❗️Нагадування: What are blackout queues and how do they work? A handy infographic.
Keep it for yourself and send it to your loved ones!
ТРУХА⚡️Україна | Send news
t.me/c/1199360700/124183 ↩ Инсайдер Киев
Инсайдер Киев
[TRANSLATED MESSAGE]
⚡️Киевская region: updated shutdown schedules for October 22
Insider Kiev
t.me/KyivPolitic/56117 ↩ Инсайдер Киев
Инсайдер Киев
t.me/KyivPolitic/56118 ↩ МВС України
МВС України
[TRANSLATED MESSAGE]
🏫 Deputy Minister of Internal Affairs of Ukraine Kateryna Pavlichenko commented on the Law on Strengthening Security Measures in Secondary Education Institutions on the air of the "United News" telethon
The law regulates approaches to the organization of a safe educational environment and provides for:
🔹 fencing the territory of schools and defining its boundaries
installation of panic buttons (currently 98.5% of schools are already equipped with them)
🔹 Restricting access to unauthorized persons, including those in a state of intoxication or with dangerous objects
🔹 not allowing people with a criminal record, those guilty of offenses against sexual inviolability, as well as those who have been prosecuted for domestic violence, bullying or failure to fulfill child-rearing responsibilities
Separately, Kateryna Pavlichenko emphasized that security measures are funded exclusively by the school founder or other authorized sources. Parental participation in financing such measures is expressly prohibited by law.
✔️ A safe educational environment is not a formality, but a necessary condition for learning. We will continue to work on the following legislative initiatives to ensure systemic protection of children in schools," the Deputy Minister said.
🇺🇦Підписатися | Minister | Ministry of Internal Affairs | Offensive Guard
t.me/mvs_ukraine/55309 ↩ ЛС: новини Львів
ЛС: новини Львів
[TRANSLATED MESSAGE]
"Green Corridor" did not help: customs officers found smuggling of CBD vapes
At the Shehyni-Medica checkpoint, customs officers stopped a Mercedes-Benz Sprinter minibus driven by a 32-year-old resident of the Dnipro region.
The man chose the "green corridor," but during the inspection, border guards and customs officers found 1094 e-cigarettes in the luggage compartment, allegedly containing cannabidiol (CBD), which has psychoactive properties.
The preliminary value of the seized goods on the black market is about UAH 1.5 million.
Send us photos/videos/information ➡️ @lviv24x7_bot
🇺🇦 LS: Lviv news
t.me/c/1687769706/45013 ↩ ЛС: новини Львів
ЛС: новини Львів
t.me/c/1687769706/45014 ↩ ЛС: новини Львів
ЛС: новини Львів
t.me/c/1687769706/45015 ↩ ЛС: новини Львів
ЛС: новини Львів
t.me/c/1687769706/45016 ↩ Оперативний ЗСУ
Оперативний ЗСУ
[TRANSLATED MESSAGE]
We will talk about the use of not only the latest Gripen E, but also the supply of older Gripen models, a dialogue is underway - Zelenskyy
https://t.me/operativnoZSU/
t.me/operativnoZSU/194937 ↩ NEXTA Live
NEXTA Live
[TRANSLATED MESSAGE]
🇰🇷 South Korea switches from Russian coal to Colombian coal
South Korea has sharply reduced purchases of Russian thermal coal, switching to Colombian supplies. The reasons are lower prices, absence of sanctions risks and flexible terms from Colombian companies: they offer discounts and partially cover freight.
In September, coal exports from Russia to South Korea fell by 14% to 2.7 million tons. By October, the decline intensified: in the first week of October alone, Colombia almost doubled its deliveries to 1.3 million tons, of which 310,000 tons were sent to Seoul.
Experts estimate that Russia supplied only 1.1 million tons in the first 20 days of October, indicating a further decline.
@nexta_live
t.me/nexta_live/105180 ↩ Оперативний ЗСУ
Оперативний ЗСУ
[TRANSLATED MESSAGE]
Gripen E is the newest Swedish aircraft, its production is just starting, the first deliveries will begin in about three years, - Swedish Prime Minister Kristersson
https://t.me/operativnoZSU/
t.me/operativnoZSU/194936 ↩ Труха⚡️Україна
Труха⚡️Україна
[TRANSLATED MESSAGE]
Today, the Rada voted down Dmytro Razumkov's amendment #2642, which would have directed UAH 1 billion of party funding to the Armed Forces.
Even those who talk about supporting the military on every broadcast did not vote, even though the amendment was supported by the relevant committee.
Only 193 MPs voted in favor. The rest?
ТРУХА⚡️Україна | Send news
t.me/c/1199360700/124182 ↩ Україна 24/7 - новини
Україна 24/7 - новини
[TRANSLATED MESSAGE]
❗️Зеленский has signed an agreement with Sweden on Ukraine's intentions to buy up to 150 Gripen fighter jets - Swedish Prime Minister Ulf Kristersson.
Ukraine 24/7
t.me/ukraina_novosti/101666 ↩ Ukraine NOW
Ukraine NOW
[TRANSLATED MESSAGE]
Ukraine to buy 120-150 newest Swedish Gripen fighters
Today, Volodymyr Zelenskyy and Swedish Prime Minister Ulf Kristersson signed an agreement on intentions to supply Ukraine with Gripen fighter jets.
"This agreement is not aimed at any deliveries at this particular moment. It is about 120-150 Gripen E-series fighters, which are now starting to be produced. This will allow us to build a very serious Air Force of Ukraine. This is the beginning of a long journey of 10-15 years," Kristersson said.
Zelenskyy confirmed that Ukraine has already trained and is training pilots on the Gripen. "Next year should be the beginning of the use of these aircraft," he said.
t.me/UkraineNow/76009 ↩ Україна 24/7 - новини
Україна 24/7 - новини
[TRANSLATED MESSAGE]
❗️рф lost more than one million people - one million three hundred thousand - Zelensky.
Ukraine 24/7
t.me/ukraina_novosti/101665 ↩ Важные истории
Важные истории
[TRANSLATED MESSAGE]
Along with the blocking of WhatsApp and Telegram in Russia, FaceTime began to malfunction
Russian users of Apple's FaceTime application for audio and video calls are complaining about problems with the service, iPhones.ru reported.
Since October 18, users have reported that FaceTime fails to establish a connection, with calls experiencing a long delay or dropping out altogether, although the Internet connection is stable.
"Rossiyskaya Gazeta" also noted that FaceTime does not work well for users in Russia. The newspaper adds that there are problems with downloading contacts in the application.
iPhones.ru notes that problems appear when working through both mobile and home Internet.
Internet security expert Mikhail Klimarev believes that this is how Russia started blocking all voice calls over the Internet.
Users from Russia told Important Stories that when they reinstall the FaceTime app, the first call goes through without problems. Repeated calls no longer work.
After the restriction of voice calls in messengers, FaceTime remained one of the few alternatives for making calls to Russia from abroad.
On September 3, the State Duma said that scammers allegedly started using FaceTime. Sergei Gavrilov, head of the Duma's Property Committee, complained that end-to-end encryption in the application was hindering investigations.
❓ Roskomnadzor confirmed today that it has begun partial blocking of messengers WhatsApp and Telegram. Since yesterday, problems with these services began for residents of southern regions of Russia. Today, the messengers are also functioning with interruptions in Moscow, St. Petersburg, Tatarstan, Siberia, the Urals and the Far East.
Only some functions of messengers are restricted, and not all operators are experiencing problems. It is unclear whether Roskomnadzor is trying to establish blocking of voice calls or to start full blocking of services.
YouTube | Telegram | X | Instagram
t.me/istories_media/10621 ↩ Україна 24/7 - новини
Україна 24/7 - новини
[TRANSLATED MESSAGE]
❗️Украина is ready for negotiations, but not on the terms of giving up unoccupied territories - Zelensky.
Ukraine 24/7
t.me/ukraina_novosti/101664 ↩ Труха⚡️Україна
Труха⚡️Україна
[TRANSLATED MESSAGE]
Cheese burgers are back at McDonald's.
You can buy them now:
▪️Біг Chicken Cheese.
▪️Біг Beef Cheese.
▪️Сир Brie.
▪️Картопля Fries with cheese sauce and bacon.
ТРУХА⚡️Україна | Send news
t.me/c/1199360700/124180 ↩ Труха⚡️Україна
Труха⚡️Україна
t.me/c/1199360700/124181 ↩ Реальна Війна | Україна | Новини
Реальна Війна | Україна | Новини
[TRANSLATED MESSAGE]
❗️В next year we will start using Gripen aircraft - Zelenskyy confirmed that Ukraine has already trained and is training pilots
🇺🇦Реальна War | Subscribe
t.me/voynareal/124461 ↩ NEXTA Live
NEXTA Live
[TRANSLATED MESSAGE]
❕ Ukraine creates its own new-generation air force: agreement signed for the purchase of up to 150 Swedish Gripen aircraft
Volodymyr Zelensky and Swedish Prime Minister Ulf Kristersson signed an agreement on intentions to purchase 120-150 newest Gripen E fighters.
According to Kristersson, this is "the beginning of a long journey of 10-15 years" rather than immediate deliveries. But if the deal goes through, it will be the largest defense contract in Swedish history, double previous records.
The Gripen E is one of the world's most advanced light fighters, capable of operating from short runways and integrating with NATO weapons.
For Ukraine, this means building a new air force with Western architecture and combat capabilities.
@nexta_live
t.me/nexta_live/105179 ↩ ЛС: новини Львів
ЛС: новини Львів
[TRANSLATED MESSAGE]
⚖️ Man to stand trial for attempted robbery and gas station robbery
It happened in Sheptytsky district in the evening of May 18. He parked his car in a forest belt, covered his face with a T-shirt and entered a gas station. He attacked the cashier, took 13 thousand hryvnias and fled.
On the same day, he tried to rob another gas station, but the cashier resisted, and an employee of the station noticed the attacker's actions - the man ran away.
The police quickly detained him. The defendant is currently in custody without bail.
Send us photos/videos/information ➡️ @lviv24x7_bot
🇺🇦 LS: Lviv news
t.me/c/1687769706/45010 ↩ ЛС: новини Львів
ЛС: новини Львів
t.me/c/1687769706/45011 ↩ ЛС: новини Львів
ЛС: новини Львів
t.me/c/1687769706/45012 ↩ Obozrevatel.ua
Obozrevatel.ua
[TRANSLATED MESSAGE]
UPD: In Kyiv, the number of victims of the enemy attack on the capital has increased to 30 people - Klitschko
Five of them are children. Doctors hospitalized 9 victims, including four children.
All others are undergoing outpatient treatment.
Details
t.me/uaobozrevatel/193228 ↩ INSIDER UA
INSIDER UA
[TRANSLATED MESSAGE]
These are very cool airplanes for a wide range of missions - President Zelensky on the Gripen
Subscribe to INSIDER UA | Submit content
t.me/insiderUKR/109486 ↩ Оперативний ЗСУ
Оперативний ЗСУ
[TRANSLATED MESSAGE]
Next year may be the beginning of Gripen aircraft use - Zelenskyy
It is necessary to prepare a framework agreement. But pilots are already preparing, equipment and infrastructure are being prepared
https://t.me/operativnoZSU/
t.me/operativnoZSU/194935 ↩ STERNENKO
STERNENKO
[TRANSLATED MESSAGE]
Ukraine and Sweden sign an agreement of intent to purchase new JAS 39 Gripen E fighters for the Ukrainian Air Force.
"This agreement is not aimed at any deliveries at this particular moment. About 120-150 Gripen E series fighters, which are now starting to be produced. This will allow us to build a very serious Air Force of Ukraine. This is the beginning of a long journey of 10-15 years," Swedish Prime Minister Ulf Kristersson Christersson.
Zelenskyy: The teams of Ukraine and Sweden must do everything to ensure that next year will be the time to start using Gripen fighters.
t.me/ssternenko/50971 ↩ Труха⚡️Україна
Труха⚡️Україна
[TRANSLATED MESSAGE]
😱OGO. Ukraine will buy 100-150 new JAS 39 Gripen E fighters: an agreement of intent to purchase this number of fighters for the Ukrainian Air Force has been signed with Sweden.
ТРУХА⚡️Україна | Send news
t.me/c/1199360700/124179 ↩ INSIDER UA
INSIDER UA
[TRANSLATED MESSAGE]
⚡️Украина and Sweden have signed a letter of intent to purchase 100-150 new JAS 39 Gripen E fighters for the Ukrainian Air Force.
Subscribe to INSIDER UA | Submit content
t.me/insiderUKR/109485 ↩ Реальна Війна | Україна | Новини
Реальна Війна | Україна | Новини
[TRANSLATED MESSAGE]
⚡️Україна and Sweden have signed an agreement of intent to purchase 100-150 new JAS 39 Gripen E fighters for the Ukrainian Air Force.
🇺🇦Реальна War | Subscribe
t.me/voynareal/124460 ↩ Оперативний ЗСУ
Оперативний ЗСУ
[TRANSLATED MESSAGE]
Swedish Gripen aircraft may be in Ukraine!
A letter of intent on long-term cooperation has been signed, according to which 100-150 new Gripen E fighters may be delivered.
↪SO__1FAE1↩https://t.me/operativnoZSU/
t.me/operativnoZSU/194934 ↩ Инсайдер Киев
Инсайдер Киев
[TRANSLATED MESSAGE]
⚡️У Russians have a new tactic: to unbalance the left and right banks. As a result of the latest attacks, almost all the arrivals were recorded on the left bank of the Dnieper - Telegraf
On the left bank is concentrated a significant part of thermal and hydroelectric power plants. If they are destroyed, there will be a critical shortage of electricity in the east. At the same time, in the west, where nuclear power plants operate, there is a surplus - an excess of electricity that cannot be transferred to the east due to the insufficient capacity of the networks.
This may indicate a new tactic of the occupants aimed at creating a prolonged blackout in Ukraine.
Insider Kiev
t.me/KyivPolitic/56116 ↩ Obozrevatel.ua
Obozrevatel.ua
[TRANSLATED MESSAGE]
The court imposed a pre-trial restraint on Andriy Bilous, who was accused of harassing female students
The Pechersk District Court of Kyiv has imposed a pre-trial restraint on the former director of the Young Theater Andriy Bilous, who is suspected of sexually assaulting female students. According to the court's decision, he will be held in custody for two months, until December 17.
Bilous himself refused to comment after the decision was announced. His lawyers asked for a more lenient measure of restraint, but to no avail.
"This is the first story of harassment in the history of Ukraine that has reached the stage of a real investigation and notification of suspicion," said Maria Vdovychenko, the prosecutor in the case.
Read more
t.me/uaobozrevatel/193224 ↩ INSIDER UA
INSIDER UA
[TRANSLATED MESSAGE]
⚡️У Russians have a new tactic: to unbalance the left and right banks. As a result of the latest attacks, almost all the arrivals were recorded on the left bank of the Dnieper - Telegraf
On the left bank is concentrated a significant part of thermal and hydroelectric power plants. If they are destroyed, there will be a critical shortage of electricity in the east. At the same time, in the west, where nuclear power plants operate, there is a surplus - an excess of electricity that cannot be transferred to the east due to the insufficient capacity of the networks.
This may indicate a new tactic of the occupants aimed at creating a prolonged blackout in Ukraine.
Subscribe to INSIDER UA | Submit content
t.me/insiderUKR/109484 ↩ Реальна Війна | Україна | Новини
Реальна Війна | Україна | Новини
[TRANSLATED MESSAGE]
"Does M.S.L. play outside the rules? The state lottery operator associated with the head of the Tax Committee Danylo Hetmantsev actually accepts sports betting without a license - Telegraph
Under the guise of the Sportprognoz lottery, the company offers classic betting - bets on football matches. M.S.L. is not listed in the register of the new regulator PlayCity, and the permit from the Ministry of Finance covers only lotteries.
The bookmaker's license costs about 240 million hryvnias. This is the amount of money the budget could receive if everyone played by the law.
🇺🇦Реальна War | Subscribe
t.me/voynareal/124459 ↩ Оперативний ЗСУ
Оперативний ЗСУ
[TRANSLATED MESSAGE]
💰 Collecting donations on behalf of a famous Hero of Ukraine: Kyiv police expose fraudsters
👮♂️ Kyiv cyberpolice, together with investigators of the Sviatoshyno District Police Department and under the procedural guidance of the Sviatoshyno District Prosecutor's Office, stopped the activities of persons who in 2024-2025 were raising funds allegedly for the needs of the Armed Forces, but in fact misappropriated them.
The criminals created several fake accounts on TikTok 🥳 using the name and video of a well-known Ukrainian serviceman who was awarded the title of Hero of Ukraine by the President of Ukraine for personal courage and heroism. On his behalf, they urged users to donate to "support the unit" and spent the money on themselves.
✔️ The police have already identified seven deceived citizens. The organizers were residents of Odesa region, including a minor. Cell phones, bank cards and other evidence were seized during the searches.
📖 The suspects were served a notice of suspicion under Part 4 Art. 190 of the Criminal Code (fraud). The adult suspects were taken into custody, the minor was placed under house arrest.
⚙️ The investigation is ongoing to identify all accomplices and victims.
🔗 Read more on the website.
ℹ️ How to protect yourself from such schemes - read the recommendations of the cyber police.
We are online: 👥FB | 🌐Web | 🕊X | 💬Vb | ✈️TG
t.me/operativnoZSU/194930 ↩ Оперативний ЗСУ
Оперативний ЗСУ
t.me/operativnoZSU/194932 ↩ Оперативний ЗСУ
Оперативний ЗСУ
t.me/operativnoZSU/194933 ↩ Оперативний ЗСУ
Оперативний ЗСУ
t.me/operativnoZSU/194931 ↩ Obozrevatel.ua
Obozrevatel.ua
[TRANSLATED MESSAGE]
US senators begin preparing three bills to increase pressure on Russia - Axios
If passed, the bills will allow a bipartisan group of senators to gain momentum for action against Moscow. Sources also claim that by this decision, congressmen will send "a signal that Washington is ready for escalation."
Chairman of the Foreign Affairs Committee James Risch emphasized that the Congress intends to do as much as possible to rebuff Russia.
It is noteworthy that the committee's decision will coincide with NATO Secretary General Mark Rutte's visit to Washington.
Read more
t.me/uaobozrevatel/193223 ↩ ЛС: новини Львів
ЛС: новини Львів
[TRANSLATED MESSAGE]
❗️У SBU confirms that the culprit in drunken road accident was its employee - media
"Comprehensive measures are being taken to clarify all the circumstances of the incident and bring the culprit to justice. The SBU considers this behavior of its employee to be absolutely unacceptable and has already launched an internal investigation, which will result in appropriate personnel decisions," the SBU commented on the shameful incident.
Send us photos/videos/information ➡️ @lviv24x7_bot
🇺🇦 LS: Lviv news
t.me/c/1687769706/45009 ↩ Реальна Війна | Україна | Новини
Реальна Війна | Україна | Новини
[TRANSLATED MESSAGE]
💡 Hourly power outage schedules in Kyiv and the region published
🇺🇦Реальна War | Subscribe
t.me/voynareal/124455 ↩ Реальна Війна | Україна | Новини
Реальна Війна | Україна | Новини
t.me/voynareal/124456 ↩ Реальна Війна | Україна | Новини
Реальна Війна | Україна | Новини
t.me/voynareal/124458 ↩ Реальна Війна | Україна | Новини
Реальна Війна | Україна | Новини
t.me/voynareal/124457 ↩ NEXTA Live
NEXTA Live
[TRANSLATED MESSAGE]
Roskomnadzor recognized the partial blocking of Telegram and WhatsApp in Russia
Problems with access to Telegram and WhatsApp in many regions of Russia continue for the third day in a row.
According to Downdetector and disruption.rf, failures are recorded in at least 20 regions - from Moscow and St. Petersburg to Siberia and the south of the country.
Roskomnadzor confirmed that it was partially restricting the messengers' work "to counter criminals".
Representatives of the main censorship agency claim that foreign services are allegedly "used to extort, deceive and involve citizens in extremist activities."
Experts believe that the authorities are testing a new traffic filtering system - TSPU. Mikhail Klimarev of the Society for the Protection of the Internet suggests that the RCN is trying a scheme to block calls and data transfer, as failures have also been recorded in FaceTime.
Users are unable to open chats, send messages or download media files: without VPN, communication has almost completely fallen off.
There is a version that Russia wants to accelerate the transition of citizens to the Chekist Max by blocking all independent messengers.
@nexta_live
t.me/nexta_live/105177 ↩ Obozrevatel.ua
Obozrevatel.ua
[TRANSLATED MESSAGE]
Several reasons why the Trump-Putin meeting in Budapest will not take place and why the US president made it all up. And why it doesn't change anything. Interview with Portnikov
In a series of diplomatic impulses in recent days, the likelihood of a second Trump-Putin summit in Budapest happening soon has diminished markedly. Preliminary arrangements for preparatory talks, including a phone call between US Secretary of State Marco Rubio and Russian Foreign Minister Lavrov, have exposed not only the technical difficulties of organizing a meeting, but also deeper changes in the parties' expectations of the basis for peace. After the talks, Washington and Moscow reportedly had different ideas about what should constitute the beginning of a ceasefire, a symptom that makes the summit more of a risky diplomatic lottery than a tool for immediate resolution.
The Kremlin has virtually rejected the idea of "freezing" the front at the current line as a final solution, a position that destroys the optimistic expectations of supporters of a quick peace compromise. The point of disagreement is obvious: Trump speaks of "stopping where the troops are," while Moscow demands a broader "comprehensive peace," which in practice would mean political concessions by Kyiv. If so, the summit risks becoming a platform for symbolic gestures and international maneuvers rather than real peace. And according to the White House, "there are no plans for President Trump to meet with Putin in the near future." Moreover, according to reports from Washington, a face-to-face meeting between Rubio and Lavrov is also "no longer necessary."
Political analyst and publicist Vitaliy Portnikov shared his thoughts on these and other topical issues in an exclusive interview with OBOZ.UA.
t.me/uaobozrevatel/193222 ↩ INSIDER UA
INSIDER UA
[TRANSLATED MESSAGE]
⚡️Графики light outages in Kiev and region for today
Subscribe to INSIDER UA | Submit content
t.me/insiderUKR/109480 ↩ INSIDER UA
INSIDER UA
t.me/insiderUKR/109481 ↩ INSIDER UA
INSIDER UA
t.me/insiderUKR/109483 ↩ INSIDER UA
INSIDER UA
t.me/insiderUKR/109482 ↩ Труха⚡️Україна
Труха⚡️Україна
[TRANSLATED MESSAGE]
The company is looking for a food taster for corporate events - they pay 8,000 UAH per shift. The schedule is free, the company covers transportation costs.
And eRobot has an unusual vacancy for a memologist. You need to review up to 200 memes a day and select the funniest ones. The salary is 38,000 UAH per month, with possible bonuses.
When someone tells you that it is impossible to make money in Ukraine, show them the eRobota channel. They publish small part-time jobs that can bring in 40,000 UAH per month.
And it doesn't matter if you have a full-time job or not - most options can be combined with your main job.
Subscribe and you'll always have an extra thousand in your pocket: https://t.me/+xhDgSLZJgxFhMjJi
#promo
t.me/c/1199360700/124178 ↩ Служба безпеки України
Служба безпеки України
[TRANSLATED MESSAGE]
SBU materials help to sentence to 15 years in prison an agent of the Russian Federation's FSB who committed sabotage at Ukrzaliznytsia and prepared a terrorist attack in the shopping center
SBU evidence helped to sentence another Russian agent operating in Kyiv region to 15 years in prison with confiscation of property. On the order of the Russian special operations forces, the offender committed sabotage at Ukrzaliznytsia and prepared terrorist attacks on the facilities of the Defense Forces.
The SBU CI detained the enemy accomplice in May this year when he was preparing an improvised explosive device to blow up a local shopping center.
According to the investigation, the enemy's task was carried out by a 25-year-old unemployed man from Bucha district, recruited by the occupiers.
Initially, the suspect performed "test" tasks for the curator, including setting fire to a relay cabinet on the railway line in the capital region.
After the arson, the agent received instructions from his supervisor to manufacture explosives on his own, which he was to plant near the military registration and enlistment office for remote detonation.
During the detention, the SBU seized components for a homemade bomb and a smartphone with evidence of his contacts with the occupiers.
Based on the SBU counterintelligence and investigative materials, the court found the offender guilty under Part 2 Article 28, Part 2 Article 113 of the Criminal Code of Ukraine (sabotage committed by a group of persons under martial law).
The investigation was conducted by the SBU Office in Kyiv and Kyiv region under the supervision of the Kyiv Region Prosecutor's Office.
t.me/SBUkr/16130 ↩ INSIDER UA
INSIDER UA
[TRANSLATED MESSAGE]
⚡️Золото is sharply cheaper: its price has fallen by almost 8% in two days. This is one of the biggest two-day drops since 2013
The fall reduced market capitalization by more than $2.5 trillion.
Subscribe to INSIDER UA | Submit content
t.me/insiderUKR/109478 ↩ INSIDER UA
INSIDER UA
t.me/insiderUKR/109479 ↩ StopFake
StopFake
[TRANSLATED MESSAGE]
‼ Anonymous Telegram channels are spreading reports that residents of Sumy region are allegedly being compensated for destroyed housing in the form of stoves. As "proof" they cite the publication of the mayor of Shostka, Mykola Noga, on the provision of compensation.
💬 "Citizens who have lost their homes can count on a metal stove. It is probably very convenient to warm yourself on the ruins. After all, no one will provide housing for the victims," such publications say. 🤥
✅ In fact, propaganda Telegram channels present the initiative of the Shostka authorities to partially compensate for the cost of "stoves" as "payment of compensation for destroyed housing with metal stoves". It is only a matter of supporting residents who install autonomous heating sources after Russian strikes on the power grid. See more: https://fmm.io/12Ox
t.me/StopFake/6215 ↩ Реальна Війна | Україна | Новини
Реальна Війна | Україна | Новини
[TRANSLATED MESSAGE]
🏆 The winners of the NCrypto Awards 2025 have been announced!
In October, the largest crypto conference in Ukraine - NCrypto 2025 - took place, bringing together leading experts, investors, and industry enthusiasts.
One of the main events was the NCrypto Awards 2025 ceremony, where the world's best crypto developers were recognized.
💡 FFA Academy has once again confirmed its status as a leader in crypto education by receiving the award "For Contribution to Cryptocurrency Education".
This once again proves the high quality of the academy's training programs and the real results of students.
"The most important thing for us is the quality of the educational product, because the results of our students depend on it. We are constantly improving our programs and approaches. This award is proof that we are moving in the right direction. But the results of our students, which are reflected in the open Dashboard, speak for us best," said Oleksandr Orlovsky, founder of the FFA Academy.
🏅 Nikita Velikanov, Chief Algorithmic Trading Analyst at FFA, received the award on behalf of the academy. He also made a presentation at the conference on the benefits of algorithmic trading in cryptocurrencies.
"We are honored to receive this award. I know how much effort we put into providing students with the best education possible. At the academy, I teach algorithmic trading, and I see how the knowledge changes the approach of our students to the crypto market," said Nikita Velikanov, a speaker at FFA Academy.
🇺🇦Реальна War | Subscribe
t.me/voynareal/124454 ↩ Инсайдер Киев
Инсайдер Киев
[TRANSLATED MESSAGE]
❗️Киев: shutdown schedules for Oct. 22
Insider Kiev
t.me/KyivPolitic/56114 ↩ Инсайдер Киев
Инсайдер Киев
t.me/KyivPolitic/56115 ↩ Реальна Війна | Україна | Новини
Реальна Війна | Україна | Новини
[TRANSLATED MESSAGE]
💡Up to 3 queues operate simultaneously: hourly power outage schedules are introduced throughout (!) Ukraine from 16:00 - Ukrenergo
🇺🇦Реальна War | Subscribe
t.me/voynareal/124453 ↩ Obozrevatel.ua
Obozrevatel.ua
[TRANSLATED MESSAGE]
From 16:00 to 22:00, power limitation schedules for industrial consumers will be in effect in all regions of Ukraine - Ukrenergo
t.me/uaobozrevatel/193221 ↩ STERNENKO
STERNENKO
[TRANSLATED MESSAGE]
In Zaporizhzhia, the number of people injured in the Russian attack has risen to 15. Among them are two infants and a 13-year-old boy.
In the capital, the number of wounded has already reached 29, five of whom are children.
t.me/ssternenko/50968 ↩ STERNENKO
STERNENKO
t.me/ssternenko/50969 ↩ Оперативний ЗСУ
Оперативний ЗСУ
[TRANSLATED MESSAGE]
‼️В all regions where emergency outages were previously used, hourly outage schedules will be introduced from 16:00 - Ukrenergo
Outages - up to three queues simultaneously
Also, from 16:00 to 22:00, power limitation schedules for industrial consumers will be in effect in all regions of Ukraine
↪SO__1FAE1↩https://t.me/operativnoZSU/
t.me/operativnoZSU/194929 ↩ Україна 24/7 - новини
Україна 24/7 - новини
[TRANSLATED MESSAGE]
❗️С 16:00 hourly shutdown schedules will be introduced across Ukraine - Ukrenergo.
Ukraine 24/7
t.me/ukraina_novosti/101663 ↩ Инсайдер Киев
Инсайдер Киев
[TRANSLATED MESSAGE]
❗️С 16:00 hourly shutdown schedules will be introduced across Ukraine - Ukrenergo
Insider Kiev
t.me/KyivPolitic/56113 ↩ INSIDER UA
INSIDER UA
[TRANSLATED MESSAGE]
❗️С 16:00 hourly shutdown schedules will be introduced across Ukraine - Ukrenergo
Subscribe to INSIDER UA | Send content
t.me/insiderUKR/109477 ↩ Труха⚡️Україна
Труха⚡️Україна
[TRANSLATED MESSAGE]
❗️До 3 queues simultaneously: In ALL REGIONS where emergency outages were previously applied, hourly outage schedules (HOS) will be introduced from 16:00.
ТРУХА⚡️Україна | Send news
t.me/c/1199360700/124176 ↩ Оперативний ЗСУ
Оперативний ЗСУ
[TRANSLATED MESSAGE]
More young Ukrainians aged 18-22 come to Germany after easing travel rules - media
At the request of the media, the German Ministry of the Interior confirmed that this number increased from 19 people per week in mid-August to more than a thousand people per week in mid-September. In October, the numbers continued to grow, with between 1,400 and almost 1,800 young Ukrainians arriving in Germany per week.
https://t.me/operativnoZSU/
t.me/operativnoZSU/194928 ↩ Obozrevatel.ua
Obozrevatel.ua
[TRANSLATED MESSAGE]
The Kremlin sent a "signal" to Trump on peace talks: ISW explains what's behind recent statements
The Kremlin has sent another signal to US President Donald Trump regarding peace talks to end the war in Ukraine. Moscow is not going to agree to his proposal for an immediate ceasefire.
Russian Foreign Minister Lavrov said that the aggressor state insists on Ukraine's complete surrender, and that a ceasefire is "incompatible with Russia's military goals." The statements of the head of Russian diplomacy were analyzed by the Institute for the Study of War (ISW).
Read more
t.me/uaobozrevatel/193220 ↩ NEXTA Live
NEXTA Live
[TRANSLATED MESSAGE]
📸 What's left of the kindergarten in Kharkiv
According to the head of the Kharkiv OVA Oleg Sinegubov, the Russians were aiming at the building - three Shaheds hit there. All 48 children were in shelter at the time of the attack and were not hurt, but four adults were injured.
Overall in the city overnight - one dead and six wounded.
The Russian Defense Ministry reported on the night shelling, but Kharkiv is not mentioned at all in their statement 😡
@nexta_live
t.me/nexta_live/105173 ↩ NEXTA Live
NEXTA Live
t.me/nexta_live/105174 ↩ NEXTA Live
NEXTA Live
t.me/nexta_live/105176 ↩ NEXTA Live
NEXTA Live
t.me/nexta_live/105175 ↩ INSIDER UA
INSIDER UA
[TRANSLATED MESSAGE]
⚡️Украинцам should prepare for forced shutdowns of water, gas and light this winter - ex-energy minister Prodan
"As for saving, of course, to reduce the consumption of energy carriers is necessary for everyone. But without forced shutdowns and schedules, unfortunately, we will not do without. Given the nature of the Russians' attacks, and even taking into account the experience that the energy sector has in restoring damaged facilities, we need to prepare for restrictions, interruptions in the supply of water, gas, and light."
Subscribe to INSIDER UA | Send content
t.me/insiderUKR/109476 ↩ Реальна Війна | Україна | Новини
Реальна Війна | Україна | Новини
[TRANSLATED MESSAGE]
💡Updated! Due to the nighttime shelling of Kyiv's thermal power plants and hydroelectric power plants, we are publishing changes to the schedules of power and water outages for Kyiv and the region.
Check your turn here:
https://kyiv.svitlo-ua.bot
t.me/voynareal/124452 ↩ Ukraine NOW
Ukraine NOW
[TRANSLATED MESSAGE]
Donations were collected on behalf of a famous Hero of Ukraine: Kyiv police expose fraudsters
The criminals created a number of fake accounts on a popular social network using the real name of a well-known Ukrainian serviceman who was awarded the title of Hero of Ukraine by the President of Ukraine.
On the fake accounts, the criminals posted real videos of the soldier and, posing as his name, raised funds allegedly for the needs of the unit. Later, they spent the fraudulently raised funds on their own needs.
They were three residents of Odesa region, one of whom is a minor. The criminals were served a notice of suspicion. They face up to eight years in prison.
t.me/UkraineNow/76008 ↩ Obozrevatel.ua
Obozrevatel.ua
[TRANSLATED MESSAGE]
Number of victims of Russian UAV strike on kindergarten and nearby houses in Kholodnohirsk district of Kharkiv increases to 9, - SES
One person was killed.
Details
t.me/uaobozrevatel/193211 ↩ Obozrevatel.ua
Obozrevatel.ua
t.me/uaobozrevatel/193219 ↩ Obozrevatel.ua
Obozrevatel.ua
t.me/uaobozrevatel/193218 ↩ Obozrevatel.ua
Obozrevatel.ua
t.me/uaobozrevatel/193215 ↩ Obozrevatel.ua
Obozrevatel.ua
t.me/uaobozrevatel/193217 ↩ Obozrevatel.ua
Obozrevatel.ua
t.me/uaobozrevatel/193213 ↩ Obozrevatel.ua
Obozrevatel.ua
t.me/uaobozrevatel/193216 ↩ Obozrevatel.ua
Obozrevatel.ua
t.me/uaobozrevatel/193212 ↩ Obozrevatel.ua
Obozrevatel.ua
t.me/uaobozrevatel/193214 ↩ МВС України
МВС України
[TRANSLATED MESSAGE]
❕The number of people injured in a Russian drone strike on a kindergarten and nearby buildings in Kharkiv has risen to 9, with one person killed
A shop, a cafe, an office building and six cars were damaged. Three fires broke out, the largest one in the kindergarten, covering an area of about 500 square meters. At the time of the strike, there were 48 children in the shelter, whom rescuers, together with police and volunteers, quickly evacuated to safety.
About 60 rescuers, 13 units of SES equipment, psychologists, pyrotechnics, dog handlers, police, doctors, volunteers and utilities were involved in the response to the attack.
The fires have been extinguished and rescue operations are underway.
🇺🇦Підписатися | Minister | Ministry of Internal Affairs | Offensive Guard
t.me/mvs_ukraine/55303 ↩ МВС України
МВС України
t.me/mvs_ukraine/55307 ↩ МВС України
МВС України
t.me/mvs_ukraine/55308 ↩ МВС України
МВС України
t.me/mvs_ukraine/55306 ↩ МВС України
МВС України
t.me/mvs_ukraine/55305 ↩ МВС України
МВС України
t.me/mvs_ukraine/55304 ↩ Obozrevatel.ua
Obozrevatel.ua
[TRANSLATED MESSAGE]
A drunk teacher causes an accident in Prykarpattia: a 14-year-old student and a 21-year-old passenger are killed and injured
The fatal accident occurred on October 21 in the village of Krasna, Nadvirna district.
"According to the investigation, a 23-year-old fine arts teacher at a school in Nadvirna district, driving a Hyundai Tucson while intoxicated (1.38% ppm), lost control, drove off the road and collided with a concrete pillar. The accident killed a 14-year-old student and a 21-year-old passenger," the PGO said.
Three other minors received injuries of varying severity. All were hospitalized at the Ivano-Frankivsk Regional Children's Clinical Hospital.
More details
t.me/uaobozrevatel/193207 ↩ Obozrevatel.ua
Obozrevatel.ua
t.me/uaobozrevatel/193209 ↩ Obozrevatel.ua
Obozrevatel.ua
t.me/uaobozrevatel/193210 ↩ Obozrevatel.ua
Obozrevatel.ua
t.me/uaobozrevatel/193208 ↩ Україна 24/7 - новини
Україна 24/7 - новини
[TRANSLATED MESSAGE]
💡 The schedules of hourly blackouts have returned to Dnipropetrovsk, Kyiv and Poltava regions.
Ukraine 24/7
t.me/ukraina_novosti/101658 ↩ Україна 24/7 - новини
Україна 24/7 - новини
t.me/ukraina_novosti/101662 ↩ Україна 24/7 - новини
Україна 24/7 - новини
t.me/ukraina_novosti/101661 ↩ Україна 24/7 - новини
Україна 24/7 - новини
t.me/ukraina_novosti/101660 ↩ Україна 24/7 - новини
Україна 24/7 - новини
t.me/ukraina_novosti/101659 ↩ Оперативний ЗСУ
Оперативний ЗСУ
[TRANSLATED MESSAGE]
19th package of sanctions against Russia to be approved tomorrow, Slovakia and Hungary to support them - Bloomberg
The sanctions will include trade restrictions on Chinese and Indian companies, as well as export bans on goods used in Moscow's military-industrial complex worth more than 40 billion euros, including minerals, ceramics and rubber, add 100 shadow fleet tankers and more.
https://t.me/operativnoZSU/
t.me/operativnoZSU/194927 ↩ Инсайдер Киев
Инсайдер Киев
t.me/KyivPolitic/56112 ↩ Инсайдер Киев
Инсайдер Киев
[TRANSLATED MESSAGE]
❗️В Kyiv region introduces stabilization outage schedules instead of emergency outages - DTEK
Kyiv Insider
t.me/KyivPolitic/56111 ↩ Реальна Війна | Україна | Новини
Реальна Війна | Україна | Новини
[TRANSLATED MESSAGE]
🇰🇵Вперше 5 months later, on the eve of Trump's visit to South Korea, the DPRK deliberately launched ballistic missiles toward the Sea of Japan
The missiles flew about 350 kilometers toward the east coast. Trump is due to arrive in Korea in a few days for the APEC summit.
🇺🇦Реальна War | Subscribe
t.me/voynareal/124451 ↩ NEXTA Live
NEXTA Live
t.me/nexta_live/105172 ↩ INSIDER UA
INSIDER UA
t.me/insiderUKR/109475 ↩ Труха⚡️Україна
Труха⚡️Україна
[TRANSLATED MESSAGE]
3-year-old Amina was injured during the shelling of the Odesa-Zaporizhzhia passenger train at the station in Dnipro. The girl sustained a severe mine-blast injury. She recently completed a physical rehabilitation and psychological recovery course organized by the Rinat Akhmetov Foundation.
"I am very grateful to the Foundation. A psychologist also talked to her here. Amina has already started to speak a little. This is a significant improvement for us," says Ekaterina, the girl's mother.
As part of the Rehabilitation of Wounded Children project of the Rinat Akhmetov for Children! Foundation provides assistance to children under 18 who have been seriously injured as a result of the war.
If your children or those you know need help, write to the Foundation's messenger or call the toll-free hotline 0800 50 90 01 (open Monday through Friday).
Thanks to the program, almost 6 million children from all over Ukraine have received comprehensive support. Rinat Akhmetov to Children.
ТРУХА⚡️Україна | Send news
t.me/c/1199360700/124174 ↩ INSIDER UA
INSIDER UA
[TRANSLATED MESSAGE]
Tea with the flavor of treason: which brands continue to make money on both sides of the war - investigation
In the fourth year of the war, a large-scale investigation reveals how brands continue to make money in both Ukraine and Russia through "clean" distributors and offshore companies:
▪️Richard, Curtis, "Maysky" - from the company "May" (founded by Ukrainian Igor Lisinenko, former State Duma deputy from "United Russia"). In Ukraine, the structure changed from "Mai Ukraine" to "a woman from Poltava region", then to "an Armenian firm" and the Armenian firm "Tripol Sun".
▪️Greenfield, Tess, "Princess Nuri" - they are owned by Orimi Trade. Its representative Orima Ukraine (now TS Trade) was fined UAH 80 mln by the AMCU in 2022 for hiding beneficiaries.
▪️Basilur - co-founded by Muscovite Andrei Mareev, since 07.2023 in Moscow, distributor of "Basilur Ti Import", sales go in parallel in Ukraine and the Russian Federation.
▪️Ahmad Tea has production and official distributor in the Russian Federation.
Lawyers explain: with international distributors there are no direct prohibitions. But whether to buy tea from producers with "double standards" is a question of reputation and the conscious choice of consumers.
Subscribe to INSIDER UA | Send content
t.me/insiderUKR/109471 ↩ INSIDER UA
INSIDER UA
t.me/insiderUKR/109472 ↩ INSIDER UA
INSIDER UA
t.me/insiderUKR/109473 ↩ Реальна Війна | Україна | Новини
Реальна Війна | Україна | Новини
t.me/voynareal/124450 ↩ STERNENKO
STERNENKO
[TRANSLATED MESSAGE]
By the way, it is very convenient to deposit cryptocurrency to the Russian casino via WhitePay.
This is a reliable Ukrainian crypto startup, the company constantly helps our foundation🤝.
Thank you and encourage you to use this convenient service!
t.me/ssternenko/50967 ↩ ЛС: новини Львів
ЛС: новини Львів
[TRANSLATED MESSAGE]
Ex-police officer suspected of heroin trafficking and bribery repairs kindergarten in Lviv
This is a former police major, Andriy Stosyk, who was detained in 2019 on these suspicions. He was released from jail on bail. The investigation is still ongoing.
After leaving the service, he started his own business and has already won a tender to repair kindergarten #179 on Chukarina Street.
Last year, he won tenders worth UAH 7.5 million, and in 2025 - UAH 5.9 million. The entrepreneur has renovated the premises of educational institutions and hospitals in Lviv and the region.
Send us photos/videos/information ➡️ @lviv24x7_bot
🇺🇦 LS: Lviv news
t.me/c/1687769706/45005 ↩ Ukraine NOW
Ukraine NOW
[TRANSLATED MESSAGE]
Already 15 wounded, including three children: the number of victims of the enemy attack on Zaporizhzhia is growing
Two infants needed medical assistance: a seven-month-old boy was hospitalized, and a six-month-old child will be treated at home after receiving help. A 13-year-old boy also remained under medical supervision.
Most of the victims have shrapnel wounds, contusions, and combustion product poisoning. Fortunately, their lives are not in danger," Zaporizhzhya Regional Military Administration.
✅ We are on WhatsApp | Viber | Telegram
t.me/UkraineNow/76006 ↩ МВС України
МВС України
t.me/mvs_ukraine/55300 ↩ МВС України
МВС України
t.me/mvs_ukraine/55302 ↩ МВС України
МВС України
t.me/mvs_ukraine/55301 ↩ INSIDER UA
INSIDER UA
[TRANSLATED MESSAGE]
Russia will use aerostats with nets to defend against Ukrainian UAVs
Similar barriers were used during World War I to protect infrastructure from enemy aircraft. A chemical company in the Tula region has announced a tender for the purchase of balloons for protection for 9 million rubles. A net will be stretched between the balloons to protect them from drones.
Also, a representative of the Russian General Staff said today that the Russian army will start to recruit reservists to guard the refinery and other infrastructure facilities.
Subscribe to INSIDER UA | Send content
t.me/insiderUKR/109468 ↩ INSIDER UA
INSIDER UA
t.me/insiderUKR/109470 ↩ INSIDER UA
INSIDER UA
t.me/insiderUKR/109469 ↩ Инсайдер Киев
Инсайдер Киев
[TRANSLATED MESSAGE]
⚡️Количество injured in the Russian attack has risen to 29 people. Of them, 5 are children - Tkachenko
Insider Kiev
t.me/KyivPolitic/56110 ↩ Obozrevatel.ua
Obozrevatel.ua
[TRANSLATED MESSAGE]
UPD: As of 14:30, the number of wounded as a result of the Russian attack has increased to 29 people, - Head of the KCIA Timur Tkachenko
Among them are 5 children.
Details
t.me/uaobozrevatel/193205 ↩ Obozrevatel.ua
Obozrevatel.ua
[TRANSLATED MESSAGE]
UPD: As a result of the hostile attack on Zaporizhzhia, the number of victims increased to 15, including three children
"Two infants needed medical assistance - a seven-month-old boy was hospitalized, and a six-month-old child will be treated at home after receiving help. A 13-year-old boy also remained under medical supervision. Most of the victims have shrapnel wounds, contusions, and combustion product poisoning. Fortunately, their lives are not in danger," the OVA reported.
More details
t.me/uaobozrevatel/193204 ↩ Ukraine NOW
Ukraine NOW
[TRANSLATED MESSAGE]
Norway has allocated an additional energy aid package worth about $150 million for winter gas purchases
This was announced by Prime Minister of Norway Jonas Har Støre during a meeting with President of Ukraine Volodymyr Zelenskyy in Oslo.
t.me/UkraineNow/76005 ↩ ЛС: новини Львів
ЛС: новини Львів
[TRANSLATED MESSAGE]
A man strangled his partner during a domestic conflict: a suspect in the murder of a man is detained
It happened in Sheptytske on October 20. A body without signs of life was found in an apartment on Stepan Bandera Street. Traces of strangulation were found on the body.
The investigation established that her 47-year-old partner was involved in the murder of the 46-year-old local resident. He strangled her during a domestic conflict. The man faces 7 to 15 years in prison.
Send us photos/videos/information ➡️ @lviv24x7_bot
🇺🇦 LS: Lviv news
t.me/c/1687769706/45004 ↩ Труха⚡️Україна
Труха⚡️Україна
[TRANSLATED MESSAGE]
They tested Yars. Brazen, dirty manipulation and muscle play. He sends his regards to America.
Sit back and relax, "dear partners".
t.me/c/1199360700/124173 ↩ Оперативний ЗСУ
Оперативний ЗСУ
[TRANSLATED MESSAGE]
Intimidation of the world: Russia launched intercontinental ballistic missiles and air-launched cruise missiles during the training of its strategic nuclear forces.
Yars systems, the Bryansk submarine, and Tu-95MS long-range aircraft were involved in the training of the strategic nuclear forces.
https://t.me/operativnoZSU/
t.me/operativnoZSU/194926 ↩ Реальна Війна | Україна | Новини
Реальна Війна | Україна | Новини
[TRANSLATED MESSAGE]
❗️Ядерні training takes place in russia today - Putin says intercontinental ballistic missiles and air-launched cruise missiles have been launched
🇺🇦Реальна War | Subscribe
t.me/voynareal/124447 ↩ Труха⚡️Україна
Труха⚡️Україна
[TRANSLATED MESSAGE]
The third mental health center of the all-Ukrainian network POVERENNIA was opened in Poltava for military personnel, veterans and their families.
The POVERTY Network was founded by Victor Pinchuk and Elena Pinchuk to support those who have experienced psychological trauma due to the war. At the Poltava center of the Return, more than 4,000 defenders and their families will be able to receive free assistance from a multidisciplinary team.
The Return Center is equipped with a modern barrier-free space with rooms for individual and family therapy, a room for group sessions and a day hospitalization ward. The Poltava center meets the requirements of physical and psychological inclusiveness: everyone can seek help without fear of judgment or stigma, and an atmosphere of trust and respect for privacy is an integral part of the work of specialists.
The RETURN Network provides free psychological assistance to the military, veterans and their families. The first stage involves opening 20-25 centers across Ukraine, which will be able to support more than 100,000 soldiers and their families annually.
ТРУХА⚡️Україна | Send news
t.me/c/1199360700/124171 ↩ Україна 24/7 - новини
Україна 24/7 - новини
[TRANSLATED MESSAGE]
❗️В part of regions are introducing hourly power outage schedules instead of the emergency schedules applied earlier - Ukrenergo.
Ukraine 24/7
t.me/ukraina_novosti/101656 ↩ Оперативний ЗСУ
Оперативний ЗСУ
[TRANSLATED MESSAGE]
Norway allocates about $150 million for energy support to Ukraine to buy gas in winter - Zelenskyy
https://t.me/operativnoZSU/
t.me/operativnoZSU/194925 ↩ INSIDER UA
INSIDER UA
[TRANSLATED MESSAGE]
On the likely illegal actions of Deputy Knyazhytsky, it would be good to clarify the situation
Recently, the topic of the probable rape of a child by MP Knyazhytskyy, which the former Interior Minister Avakov, who also had a similar "fame" and using his official position at the time - hushed up, "smoothing out the rough edges", has not been closed.
It would be good for law enforcers against the background of the recent story with sexual harassment in KNU also to put an end to the case of Knyazhytskyy.
Subscribe to INSIDER UA | Send content
t.me/insiderUKR/109465 ↩ STERNENKO
STERNENKO
[TRANSLATED MESSAGE]
The SBU presented a new generation of maritime drones "Sea Baby".
The development team demonstrated two drones with different weapons:
- The first one is equipped with a gyro-stabilized machine gun, which has an auto-capture and target recognition system;
- The second one carries heavy weapons: A 10-round Grad MLRS.
t.me/ssternenko/50962 ↩ STERNENKO
STERNENKO
t.me/ssternenko/50964 ↩ STERNENKO
STERNENKO
t.me/ssternenko/50965 ↩ STERNENKO
STERNENKO
t.me/ssternenko/50963 ↩ STERNENKO
STERNENKO
t.me/ssternenko/50966 ↩ Obozrevatel.ua
Obozrevatel.ua
[TRANSLATED MESSAGE]
In some regions of Ukraine, hourly power outage schedules are being introduced instead of the previously used emergency ones - Ukrenergo
However, in some regions, emergency power outages caused by the consequences of the Russian attack continue to operate.
t.me/uaobozrevatel/193199 ↩ Реальна Війна | Україна | Новини
Реальна Війна | Україна | Новини
[TRANSLATED MESSAGE]
❗️В December-January, there will be a shortage of gas - this threat is real. That is, the heating season is in question," says MP Bondar.
🇺🇦Реальна War | Subscribe
t.me/voynareal/124446 ↩ Obozrevatel.ua
Obozrevatel.ua
[TRANSLATED MESSAGE]
The General Staff confirms the destruction of an ammunition plant and an oil refinery in Russia
As part of the reduction of the military and economic potential of the Russian aggressor, on the night of October 22, units of the Ukrainian Defense Forces struck a number of strategic facilities in Russia.
Saransk Mechanical Plant in the Republic of Mordovia was hit. Explosions were recorded on the territory of the enterprise. The plant produces anti-personnel engineering ammunition and mine kits, ammunition detonators and initiation units.
🔻The Makhachkala oil refinery in the Republic of Dagestan was hit. One of the refining units on the territory of the enterprise was hit.
The main purpose of the plant is to provide fuel and its storage in the interests of the Caspian Sea Fleet naval base and refueling of Russian occupiers' warships.
Details
t.me/uaobozrevatel/193197 ↩ Труха⚡️Україна
Труха⚡️Україна
[TRANSLATED MESSAGE]
❗️Запроваджуються schedules of hourly power outages instead of emergency outages in some regions - Ukrenergo.
ТРУХА⚡️Україна | Send news
t.me/c/1199360700/124169 ↩ Оперативний ЗСУ
Оперативний ЗСУ
[TRANSLATED MESSAGE]
In some regions, hourly power outage schedules are being introduced instead of the previously used emergency ones - Ukrenergo
In some regions, emergency blackouts are still in effect
https://t.me/operativnoZSU/
t.me/operativnoZSU/194924 ↩ INSIDER UA
INSIDER UA
[TRANSLATED MESSAGE]
❗️В hourly power outage schedules are introduced in some regions instead of the emergency schedules applied earlier - Ukrenergo
Subscribe to INSIDER UA | Send content
t.me/insiderUKR/109464 ↩ Инсайдер Киев
Инсайдер Киев
[TRANSLATED MESSAGE]
❗️Есть there is a very high risk that there will not be enough gas as early as December-January. So far, indeed, the heating season is under a big question mark, - MP Bondar
"That the energy sector, that gas production, that heating season the whole will be under a very big question mark in the state."
Insider Kiev
t.me/KyivPolitic/56109 ↩ INSIDER UA
INSIDER UA
[TRANSLATED MESSAGE]
❗️Есть there is a very high risk that there will not be enough gas as early as December-January. So far, indeed, the heating season is under a big question mark, - MP Bondar
"That the energy sector, that gas production, that heating season the whole will be under a very big question mark in the state."
Subscribe to INSIDER UA | Send content
t.me/insiderUKR/109463 ↩ Obozrevatel.ua
Obozrevatel.ua
[TRANSLATED MESSAGE]
Zelenskyy arrives on an official visit to the Kingdom of Sweden
t.me/uaobozrevatel/193196 ↩ Оперативний ЗСУ
Оперативний ЗСУ
[TRANSLATED MESSAGE]
🛩️Уражено ammunition plant and oil refinery, - General Staff
💥 Saransk Mechanical Plant in the Republic of Mordovia was hit (video) The plant produces anti-personnel engineering ammunition and mine kits, ammunition detonators and fuzes.
💥The Makhachkala oil refinery in the Republic of Dagestan was hit. One of the refining units on the territory of the enterprise was hit.
💥https://t.me/operativnoZSU/
t.me/operativnoZSU/194922 ↩ ЛС: новини Львів
ЛС: новини Львів
t.me/c/1687769706/45003 ↩ ЛС: новини Львів
ЛС: новини Львів
t.me/c/1687769706/45002 ↩ ЛС: новини Львів
ЛС: новини Львів
[TRANSLATED MESSAGE]
❗️Канабісу and psilocybin mushrooms worth over UAH 3 million seized from a group of drug traffickers
Police expose interregional group that grew elite varieties of cannabis and sold them across Ukraine
Three hydroponic drug laboratories operated in Kirovohrad region, and a sales center in Poltava region. Law enforcement officers seized more than 1750 cannabis bushes, ready-made "bookmarks", jars of cannabis and psilocybin mushrooms. The total value of the seized goods is over UAH 3 million.
The group consisted of five people: a father with two sons from Kirovohrad region and two residents of Lviv region. They sold drugs online and made "bookmarks" in Lviv.
Four were detained and all were notified of suspicion of drug trafficking and cannabis cultivation.
The court took them into custody and they face up to 10 years in prison with confiscation of property.
Send us photos/videos/information ➡️ @lviv24x7_bot
🇺🇦 LS: Lviv news
t.me/c/1687769706/44999 ↩